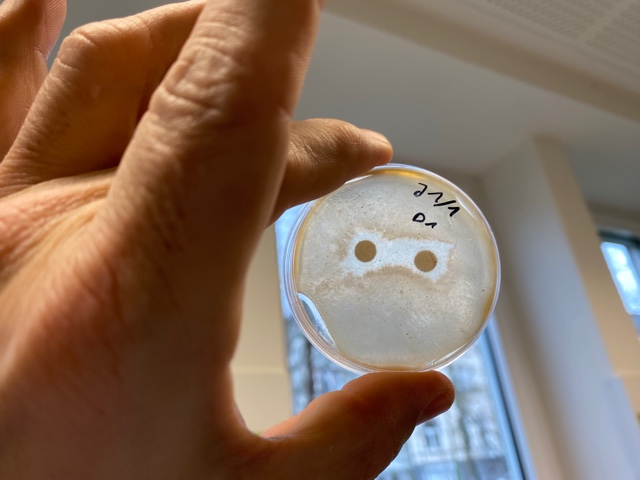

Berichte
Austausch mit Krakau - eine erlebnisreiche Woche im Juni
Gegen 20 Uhr landen wir am 13.06.2023 auf dem Flughafen in Kattowitz. Wir sind alle sehr aufgeregt. Wer wird uns am Ausgang erwarten? Werden wir uns noch so gut verstehen wie beim ersten Zusammentreffen in Linz? Wie wird es in den Familien unserer Austauschpartner/innen sein? Doch als wir durch den Ausgang laufen, sind alle Ängste erstmal weg. Dort stehen nämlich die Schülersprecherin, einige Schüler und die beiden Lehrerinnen der polnischen Schule mit einer großen Deutschlandflagge und strahlenden Gesichtern vor uns. Als wir schließlich in einem Minibus alle gemeinsam nach Krakau fahren, vergehen die zwei Stunden Fahrzeit wie im Nu. So viel haben wir uns zu erzählen.
In Krakau erwarten uns dann gespannt die restlichen polnischen Schüler/innen mit ihren Eltern. Die Bustür öffnet sich und wir fallen uns nach über einem halben Jahr mit großer Freude wieder in die Arme.
Austausch mit Krakau - eine erlebnisreiche Woche im Juni

Gegen 20 Uhr landen wir am 13.06.2023 auf dem Flughafen in Kattowitz. Wir sind alle sehr aufgeregt. Wer wird uns am Ausgang erwarten? Werden wir uns noch so gut verstehen wie beim ersten Zusammentreffen in Linz? Wie wird es in den Familien unserer Austauschpartner/innen sein? Doch als wir durch den Ausgang laufen, sind alle Ängste erstmal weg. Dort stehen nämlich die Schülersprecherin, einige Schüler und die beiden Lehrerinnen der polnischen Schule mit einer großen Deutschlandflagge und strahlenden Gesichtern vor uns. Als wir schließlich in einem Minibus alle gemeinsam nach Krakau fahren, vergehen die zwei Stunden Fahrzeit wie im Nu. So viel haben wir uns zu erzählen.
In Krakau erwarten uns dann gespannt die restlichen polnischen Schüler/innen mit ihren Eltern. Die Bustür öffnet sich und wir fallen uns nach über einem halben Jahr mit großer Freude wieder in die Arme.
Vom 13.06.2023 bis 20.06.2023 besuchten wir, 13 Schüler/innen des Martinus-Gymnasium Linz, das Don-Bosco-Lyzeum in Krakau. Schon im letzten Jahr im Oktober waren unsere Austauschschüler/innen aus Polen für eine Woche in Linz.
Die Tage nach der Ankunft boten verschiedenste Eindrücke:
• emotionale (Besuch des Konzentrationslager Ausschwitz-Birkenau, Führung in Schindlers Fabrik)
• aufregende (Besuch von Energylandia – einem Freizeitpark mit vielen Achterbahnen)
• sportliche (Volleyballtraining und -turnier, Wanderungen)
• von der Natur geprägte (Übernachtungsfahrt in die Hohe Tatra)
• spaßige (Schulparty mit Tanz).
Mein absoluter Höhepunkt der Woche war der Ausflug in die Hohe Tatra mit Volleyballspielen, Grillen, gemeinsamem Tanzen und Quatschen auf den Fluren bis in die Nacht. Das fühlte sich an wie eine Klassenfahrt mit Freunden.
Doch jeder Tag war geprägt von vielen schönen Erlebnissen und neuen Eindrücken.
Aber wie lief eigentlich ein Tag einer deutschen Austauschschülerin in Polen so ab?
Am ersten Morgen mussten meine Austauschpartnerin und ich früh aufstehen, da wir uns um 09:00 Uhr mit den anderen trafen, um gemeinsam mit der Straßenbahn in die Innenstadt von Krakau fahren.
Bevor wir aus dem Haus gingen, hatte ihre Mutter ein leckeres Frühstück zubereitet. Meine Gastfamilie kochte während meines Aufenthaltes oft traditionelle polnische Gerichte, damit ich die Möglichkeit hatte, die polnische Küche besser kennenzulernen. Deshalb gab es auch morgens schon ein typisch polnisches Frühstück: gekochte Eier, Hüttenkäse, Gurken, Tomaten, Roggenbrot und gegrillte Würstchen.
Nicht nur meine Gastfamilie, sondern auch alle anderen Eltern waren sehr gastfreundlich. So musste ich z.B. morgens weder den Tisch auf- noch abdecken noch in der Küche helfen oder das Essen vorbereiten.
Als wir in der Innenstadt von Krakau angekommen waren, wurde uns unsere Stadtführerin vorgestellt, die uns in den folgenden Stunden einige interessante Sehenswürdigkeiten in Krakau zeigte, z.B. den Wawel-Drachen, der ein Drache in der polnischen Volkssage ist. Leider regnete es während der Stadtführung, doch zum Glück hatten alle einen Regenschirm dabei, außerdem war es eine angenehme Abkühlung von dem sonst so warmen Wetter in Krakau.
Nach der Stadtführung hatten wir die Möglichkeit, Krakau in Kleingruppen selbst zu erkunden. Zum Mittagessen aßen wir in einem typisch polnischen Restaurant. Wir bestellten uns Pierogi, ein in Polen sehr verbreitetes Gericht. Pierogi sind Teigtaschen mit unterschiedlichen Füllungen. Sie schmecken köstlich. Danach trafen wir uns wieder mit den anderen, um uns auf den Weg zu Schindlers Fabrik zu machen. Da schien schon wieder die Sonne. Dort angekommen, bekamen wir eine spannende Führung durch das Museum. Zum Glück hatten wir in Vorbereitung unserer Fahrt den Film „Schindlers Liste“ gesehen, der in Krakau spielt. Im Museum entdeckten wir Alltagsgegenstände, Zeitungen und persönliche Dokumente, die aus der Zeit der Besatzung Polens durch die Deutschen während des zweiten Weltkrieges stammten. Anschließend hatten wir Freizeit, die ich mit meiner Austauschpartnerin in der Innenstadt von Krakau verbrachte, wo wir in kleinen Läden Souvenirs für meine Familie kauften.
Nicht nur an diesem Abend, sondern auch an den restlichen Abenden fielen wir immer todmüde ins Bett, da wir vor allem in Krakau viel laufen mussten. Bevor meine Austauschpartnerin und ich uns schlafen legen konnten, aßen wir abends bei ihrer Familie - häufig Fleischgerichte. Und bevor uns dann die Augen zufielen, unterhielten wir uns noch stundenlang über Gott und die Welt.
Der Krakauaustausch war für alle Teilnehmenden eine besondere Erfahrung. Diesen Besuch wird wahrscheinlich keiner so schnell vergessen und er bleibt sicher ein prägendes Erlebnis für jeden von uns.
N. Riemann, 16.07.2023
![]() |
![]() |
![]() |
![]() |
![]() |
![]() |
![]() |
![]() |
![]() |
Schwimmwoche für die JS6 am MGL
Dieses Jahr fand erstmals am MGL eine Schwimmwoche (03.07.23 – 07.07.23) für unsere Sechstklässler statt. Bei nahezu perfektem Wetter haben alle Sechstklässler es geschafft ein Abzeichen abzulegen und somit die Woche erfolgreich abzuschließen.
Schwimmwoche für die JS6 am MGL

Dieses Jahr fand erstmals am MGL eine Schwimmwoche (03.07.23 – 07.07.23) für unsere Sechstklässler statt. Bei nahezu perfektem Wetter haben alle Sechstklässler es geschafft ein Abzeichen abzulegen und somit die Woche erfolgreich abzuschließen. 24 SuS haben den Freischwimmer (Bronze Abzeichen) abgelegt, 30 SuS haben das silberne und 14 sogar das goldene Abzeichen erworben. Einige schafften es sogar mehrere Abzeichen abzulegen. Dank der Kooperation und der Unterstützung des DLRG Bad Honnef-Unkel war es möglich die Schwimmwoche in der Form dieses Jahr durchzuführen. Außerdem war es dadurch für 10 sehr gute SchwimmerInnen möglich den Juniorretter abzulegen. Vielen Dank für die Unterstützung der Sportkollegen und des DLRG Teams sowie Carsten Kolberg aus dem Freibad Linz für die kurzfristige Bereitstellung des Freibades.
Für alle Beteiligten war die Woche ein voller Erfolg und wir hoffen, dass dieser Erfolg nächstes Jahr fortgeführt werden kann.
A. Berger, 15.7.23
In der Woche vom 3.7.23 bis zum 7.7.23 hatten die 6. Klassen am MGL eine Schwimmwoche im Linzer Freibad. Wir haben uns morgens an der Schule getroffen und sind dann zusammen mit unseren Klassen ins Freibad gegangen. Dort wurden wir in verschiedene Leistungsgruppen aufgeteilt (z.B. Seepferdchen-Gruppe, Bronze bis Gold-Gruppe und Juniorretter). Wir hatten meistens drei Unterrichtsstunden Schwimmen/Springen/Tauchen und zwei Pausen. Alle Gruppen haben für das nächste Schwimmabzeichen trainiert.
Viele haben Fortschritte gemacht, zum Beispiel vom Drei-Meter-Turm zu springen oder das nächste Abzeichen zu absolvieren. An manchen Tagen war es zwar ziemlich kalt, aber am Freitag sind manche sogar noch länger im Schwimmbad geblieben Wie fanden es sehr toll, weil man zusammen mit Freunden spielen und lernen konnte.
L. Rondot, 15.7.23
![]() |
![]() |
![]() |
![]() |
Zero Waste Shop Bonn
The unpacked world of LiMa’s
On 12th June 2023, we started our trip to Bonn with our teacher Mrs Schardinel-Wassong by train to visit a special start-up company in Bonn-Beuel. The shop is called LiMa ́s fairpackte Welt. The store promises sustainable and organic products without packaging.
Before this excursion we discussed the topic Ecological Challenges in our English lessons. Our focus was on plastic, how to avoid it and which alternatives exist.
Zero Waste Shop Bonn

The unpacked world of LiMa’s
On 12th June 2023, we started our trip to Bonn with our teacher Mrs Schardinel-Wassong by train to visit a special start-up company in Bonn-Beuel. The shop is called LiMa ́s fairpackte Welt. The store promises sustainable and organic products without packaging.
Lisa, the owner, explained to us that she even makes sure that the products are delivered without plastic, only packed in paper. One exception are the big plastic containers, which can be used multiple times.
With her first ideas the young woman started in February 2020 and the shop opened in September 2021.
Before this excursion we discussed the topic Ecological Challenges in our English lessons. Our focus was on plastic, how to avoid it and which alternatives exist.
An interesting example of waste reduction is shampoo. At first it seems expensive to pay 9 Euros for this product, but one block of solid shampoo lasts as long as 3 bottles of liquid shampoo. And solid shampoo is packed in a piece of paper or even without anything, liquid shampoo needs plastic bottles. The price is nearly the same, but when you buy here, you keep our world clean, it is environmentally friendly.
Lisa prepared a game for us: we got pictures of products from supermarkets, and we were asked to try to find these products in the zero waste store.
I had a picture of oat milk. There was no bottle and no tetra pak, but in a jar I found oat milk powder. You mix the powder with water to get the oat milk. Jars to fill in the products are for free, so you can buy as much as you need. It is space saving and more durable.
Other products in the shop are:
- reusabel cleaning rags which you can use instead of Zewa kitchentowels
- spices in small amounts
- dishwashing liquid which can be bottled in the quantity you need
I planned to add a link, but the homepage of LiMa ́s fairpackte Welt is still under construction.
However, you are welcome to follow LiMa ´s Fairpackte Welt on instagram.
All in all, it was a very interesting experience, perhaps some of us got a new view about waste and sustainability, in any case, everyone has started to think about our planet.
M. Kamper, 14.07.2023
Bundestagsabgeordnete diskutierten mit Schülern am Martinus-Gymnasium Linz
Auf Einladung der SV und des Fachbereichs Sozialkunde besuchten am Dienstag, den 27.06.2023, die Bundestagsabgeordneten Sandra Weeser (FDP), Erwin Rüddel (CDU), Martin Diedenhofen (SPD) und Andreas Bleck (AFD) für knapp zwei Stunden das Martinus-Gymnasium Linz.
Bundestagsabgeordnete diskutierten mit Schülern am Martinus-Gymnasium Linz

Auf Einladung der SV und des Fachbereichs Sozialkunde besuchten am Dienstag, den 27.06.2023, die Bundestagsabgeordneten Sandra Weeser (FDP), Erwin Rüddel (CDU), Martin Diedenhofen (SPD) und Andreas Bleck (AFD) für knapp zwei Stunden das Martinus-Gymnasium Linz.
Nachdem sich die Bundestagsabgeordneten kurz vorgestellt hatten, begann ein von dem ehemaligen SV-Mitglied Florian Augst und dem Schulleiter Thomas Schmacke moderiertes Podiumsgespräch, in dem die Themen Schulbildung/Digitalisierung, Ausbildung, Studium und Fachkräftemangel behandelt wurden.
Die politischen Gäste hatten die Möglichkeit, ihre Positionen zu den einzelnen Themen darzulegen und die Schülerinnen und Schüler konnten zu den einzelnen Themen Fragen stellen und ihre Meinungen vortragen.
In der sich daran anschließenden Fragerunde kristallisierten sich besonders zu den Themen Einwanderung von Fachkräften, Sozialleistungen, Klimaschutz, Wirtschafts- und Energiepolitik konträre politische Positionen heraus.
Die Bundestagsabgeordneten betonten, dass ihnen die Diskussionsrunde sehr viel Spaß gemacht hat und dass die pluralistische Demokratie von der Debatte auf allen Ebenen lebt. Gerade in den aktuell sehr herausfordernden Zeiten sei es entscheidend, vor allem auch mit jungen Menschen im Gespräch zu bleiben.
Die Schulgemeinschaft des Martinus-Gymnasiums bedankt sich bei den teilnehmenden Bundestagsabgeordneten für ihr Kommen und für die Möglichkeit, einen weiteren Aspekt demokratischer Diskussionsprozesse mitzuerleben!
Linz, 13.07.23
"Der Besuch der alten Dame"
Die Schüler des DS Kurses der MSS 12 begeisterten am 23.06. und 24.06. in der Linzer Stadthalle das Publikum mit einer eindrucksvollen Inszenierung von Friedrich Dürrenmatts "Der Besuch der alten Dame".
"Der Besuch der alten Dame"

Die Schüler des DS Kurses der MSS 12 begeisterten am 23.06. und 24.06. in der Linzer Stadthalle das Publikum mit einer eindrucksvollen Inszenierung von Friedrich Dürrenmatts "Der Besuch der alten Dame".
Monatelanges intensives Proben zahlte sich aus, als die Schüler die facettenreichen Figuren der Geschichte mit Ausdrucksstärke darstellten. Die Geschichte vom "Besuch der alten Dame" erzählt von Claire Zachanassian, einer wohlhabenden Frau, die in ihre Heimatstadt zurückkehrt, um Rache an ihrem ehemaligen Geliebten zu nehmen. Die Schüler schafften es, die Spannung und den moralischen Konflikt der Geschichte zu vermitteln. Neben den schauspielerischen Leistungen war auch das Bühnenbild beeindruckend. Sie hatten eine eindrucksvolle Kulisse geschaffen, die die düstere Atmosphäre der Geschichte verdeutlichte.
Diese hervorragende Theateraufführung und die Verwirrung, die durch das Wegbringen des Sargs in der Nacht der Dernière entstand, werden zweifellos in Erinnerung bleiben.
L. Hildebrandt, 10.07.23
![]() |
![]() |
Exkursion ins Adenauerhaus in Rhöndorf an unserem ersten Demokratietag
Anlässlich des ersten Demokratietages am MGL am 25. Mai 2023 fuhr eine Gruppe Schülerinnen und Schüler der Klassen 8 bis 10 zu einem Workshop ins Adenauerhaus nach Rhöndorf. Nach der Begrüßung wurden wir durch das Wohnhaus, in dem Konrad Adenauer gelebt hat, sowie durch seinen Rosengarten und an der eigens für ihn gebauten Bocciabahn vorbeigeführt.
Exkursion ins Adenauerhaus in Rhöndorf an unserem ersten Demokratietags

Anlässlich des ersten Demokratietages am MGL am 25. Mai 2023 fuhr eine Gruppe Schülerinnen und Schüler der Klassen 8 bis 10 zu einem Workshop ins Adenauerhaus nach Rhöndorf. Nach der Begrüßung wurden wir durch das Wohnhaus, in dem Konrad Adenauer gelebt hat, sowie durch seinen Rosengarten und an der eigens für ihn gebauten Bocciabahn vorbeigeführt.
Das Thema des Workshops war „Konrad Adenauer in der NS-Zeit und das Entstehen unserer Demokratie“. Dazu bekamen wir einen Fragebogen, den wir mithilfe der Informationen im Ausstellungsteil des Adenauerhauses beantworten konnten. Wir erfuhren, was das Leben und Denken Adenauers geprägt hat und beleuchteten die Aspekte: christlich-konservative Werte, Kaiserreich, Weimarer Republik, Nationalsozialismus und die Errichtung der Demokratie in der Bundesrepublik und Westeuropa mithilfe seiner französischen Amtskollegen.
Wir hatten einen spannenden Demokratietag!
T. Malottke, 10.07.23
Nachwuchs-Mathematiker/innen am MGL erfolgreich
In einer gemeinsamen Siegerehrung wurden kurz vor den Ferien die Erfolge einiger Freiwilliger ausgezeichnet, die an „Mathematik im Advent“ und/oder dem Landeswettbewerb Mathematik teilgenommen hatten. Beide mathematischen Aktivitäten werden mit einem Sternchen des MINT-Zertifikates des Landes Rheinland-Pfalz honoriert. Zusätzlich wurden von den betreuenden Lehrern Herrn Waldek (Mathe im Advent) und Herrn Meixner (Landeswettbewerb Mathematik) natürlich auch die Urkunden und kleine Sachpreise ausgegeben
Nachwuchs-Mathematiker/innen am MGL erfolgreich

In einer gemeinsamen Siegerehrung wurden kurz vor den Ferien die Erfolge einiger Freiwilliger ausgezeichnet, die an „Mathematik im Advent“ und/oder dem Landeswettbewerb Mathematik teilgenommen hatten. Beide mathematischen Aktivitäten werden mit einem Sternchen des MINT-Zertifikates des Landes Rheinland-Pfalz honoriert. Zusätzlich wurden von den betreuenden Lehrern Herrn Waldek (Mathe im Advent) und Herrn Meixner (Landeswettbewerb Mathematik) natürlich auch die Urkunden und kleine Sachpreise ausgegeben.
Beim mathematischen Adventskalender findet man - statt der immer gleichen Schokolade - jeden Tag ein neues spannendes Mathe-Rätsel. Mike Antweiler (5a), Marlene Buhr (5d), Emir Sahinbay (8c), Erik Watts (8d) und Lars Homscheid (8d) lösten alle 24 „Türchen“ richtig und haben somit eine Goldmedaille errungen!
Silbermedaillen wurden an Vincent Buhr, Jonas Chahid, Enno Siebertz, Johannes Suntrup und Tanja Swisky (alle 5d) und Bronzemedaillen an Murhaf Albatran, Diego Effern, Lara Hoffmann, Martha Schmitz, Elias Zeichner (alle 5d), Bjarne Adolphi (8b), Monia Albatran, Marie Sofie Diederich, Nils Kandels, Justin Knoop und Leonie Stahl (alle 8d) vergeben. Herzliche Glückwünsche an alle! Wir hoffen, es knobeln 2023 im Dezember wieder alle mit.
Der Landeswettbewerb Mathematik richtet sich im Rahmen der Begabtenförderung mit anspruchsvollen Aufgaben an besonders interessierte Achtklässler/innen. Am MGL konnten tatsächlich sogar schon ein paar „Frühstarter/innen“ aus den siebten Klassen einen Preis erringen: 1. Preise gingen an Vy Ngoc Seidel (8a) und Lara Martin (8b); mit einem 2. Preis wurden Emir Sahinbay (8a), Bjarne Adolphi (8b), Elias Hildebrandt (8b), Ly Nguyen (8b), Mariko Zeiler (8c), Lars Homscheid (8d), Quang Nguyen (8d) ausgezeichnet; einen 3. Preis erhielten Esmeray Ceylan, Tim Keller, Coco von Almen (alle 7a), Emma Born, Emma Ditter, Emma Hirzmann, Maximilian Warmth (alle 7c), Jolie Khazdouzian (8a), Emilia Reitz (8a), Elias Jesse (8b), Amy Wöhrle (8b), Monia Albatran (8c), Timo Kröger (8c), Timur Ivanov, Nils Kandels, Moritz Munsch, Erik Watts (alle 8d).
Alle Preisträger haben sich für die zweite Wettbewerbsrunde in der 9. Klasse qualifiziert. Herzlichen Glückwunsch und viel Erfolg für den weiteren Verlauf des Wettbewerbs.
L. Tironi, 14.06.23
Marie zur Mathe-im-Advent-Preisverleihung in Berlin
Eine unserer Schülerinnen (Marie Diederich aus der Klasse 8d) hat sogar einen Preis aus dem Pool der Sonderpreise gewonnen. Diesen dürfte sie bei der deutschlandweiten Preisverleihung in Berlin entgegennehmen. Ein tolles Erlebnis, über das sie hier kurz berichtet:
"Vor Beginn der Preisverleihung gab es einige Stationen mit verschiedenen Mathe- und MINT-Spielen. Darauf folgend begann die Preisverleihung, bei der die Gewinner einzelner Kategorien aufgerufen wurden und ihre Preise entgegen genommen haben. Anschließend wurden noch Fotos gemacht und man hatte die Möglichkeit sich bei Essen und Trinken noch zu unterhalten.“
H. Meixner, 14.06.23
![]() |
![]() |
Dauerleihgaben der Universität Bonn im Biologie-LK am MGL
Immer wieder imposant sind Experimente im Biologie-Unterricht der Oberstufe und vor allem dann, wenn sie anschauliche Ergebnisse zeigen.
Es war dem BioLK B2 der MSS 11 im Rahmen des BNE-Themenfelds „Fotosynthese – Die einzig 100%ig nachhaltige Form der Energiegewinnung“ möglich, auf beeindruckend deutliche Weise die 7 Blatt-Farbstoffe, welche die Fotosynthese antreiben, aus verschiedenen Blattextrakten zu trennen.
Dauerleihgaben der Universität Bonn im Biologie-LK am MGL

Immer wieder imposant sind Experimente im Biologie-Unterricht der Oberstufe und vor allem dann, wenn sie anschauliche Ergebnisse zeigen. Dabei bewähren sich zunehmend die Dauerleihgaben aus dem früheren Institut für Molekulargenetik der Rheinischen Friedrich-Wilhelms-Universität zu Bonn. Diese wurden von Herrn Prof. Dr. Klaus Willecke nach seiner Emeritierung vor einigen Jahren dem MGL als Dauerleihgabe dankenswerterweise überlassen.
Für die Dünnschicht-Chromatographie (DC) von Blattfarbstoffen können beispielsweise jetzt zur anfänglichen Blattzerkleinerung ein Polytron-Homogenisator und zum Auftragen der Farbstoffextrakte (s. Reagenzgläser) sog. Gilson-Pipetten verwendet werden. Auch die 8x18 cm DC-Platten sowie der Chromatographie-Tank stammen aus ehemaligen universitären Beständen.
Somit war es dem Biologie-Leistungskurs Biologie B2 der MSS 11 (s.o.) im Rahmen des BNE-Themenfelds „Fotosynthese – Die einzig 100%ig nachhaltige Form der Energiegewinnung“ möglich, auf beeindruckend deutliche Weise die 7 Blatt-Farbstoffe, welche die Fotosynthese antreiben, dünnschicht-chromatographisch aus verschiedenen Blattextrakten zu trennen.
Dr. Goran Söhl, 13.06.2023
![]() |
![]() |
„Die Zauberschaukel“ – die Zirkus-Show am MGL
Sanft schwingt die rote Tuchschaukel an einer großen Eiche. In ihr liegt ein Mädchen, das sich weg sehnt aus seinem tristen Alltag. Es träumt davon, Teil einer Zirkustruppe zu werden und mit ihr durch die Welt zu ziehen.
Plötzlich wird die Schaukel immer schneller und wilder. „Ob das wohl eine Zauberschaukel ist?“ fragt sich das Mädchen und schon schwingt es mitten hinein in die große Show, die die Zirkus-AG am 12. Mai in der Sporthalle des Martinus-Gymnasiums präsentierte.
„Die Zauberschaukel“ – die Zirkus-Show am MGL

Sanft schwingt die rote Tuchschaukel an einer großen Eiche. In ihr liegt ein Mädchen, das sich weg sehnt aus seinem tristen Alltag. Es träumt davon, Teil einer Zirkustruppe zu werden und mit ihr durch die Welt zu ziehen.
Plötzlich wird die Schaukel immer schneller und wilder. „Ob das wohl eine Zauberschaukel ist?“ fragt sich das Mädchen und schon schwingt es mitten hinein in die große Show, die die Zirkus-AG am 12. Mai in der Sporthalle des Martinus-Gymnasiums präsentierte.
Rund 20 Schülerinnen und Schüler der Jahrgangsstufen 5-8 zeigten ihren Besuchern ein buntes Programm von atemberaubenden Tricks. Elfen schweben über Drahtseile, andere bewegen sich grazil zur Musik auf dem Luftring. Da werden Flugrollen und Saltos durch Ringe und Überschläge gezeigt, Kunststücke an Trapez und Vertikaltuch werden vorgeführt. Als Fortbewegungsmittel dienen Einräder und Laufkugeln. Hula Hoops kreiseln ebenso wie Rola Bolas. Es wird auf freistehenden Leitern herumgeklettert und mit ihren Körpern bauen die Artistinnen und Artisten schwindelerregende Pyramiden.
Als das Mädchen am Ende vom Zauber-Clown zurück in seine Welt gebracht wird, ist der Beifall der großen und kleinen Besucher groß. Und wer weiß: Vielleicht träumt auch mancher Besucher ja davon, einmal auf solch eine Zauberschaukel zu treffen, die ihn in wundersame Welten entführt. Am MGL kann einem so etwas auf alle Fälle passieren…
H. Meixner, 23.05.2023
![]() |
![]() |
![]() |
![]() |
![]() |
![]() |
![]() |
![]() |
![]() |
![]() |
![]() |
![]() |
![]() |
![]() |
![]() |
![]() |

Félicitations - Das Martinusgymnasium wird zur DELF-Partnerschule ernannt
16 Jahre, über 30 Prüfungsdurchgänge, 753 (!!!) Prüflinge …. die Bilanz der DELF-AGs unter der Leitung von Frau Bücker-Kanschik und Frau Jäger kann sich sehen lassen und trägt entscheidend zum starken Fremdsprachenprofil unserer Schule bei.
Félicitations - Das Martinusgymnasium wird zur DELF-Partnerschule ernannt

16 Jahre, über 30 Prüfungsdurchgänge, 753 (!!!) Prüflinge …. die Bilanz der DELF-AGs unter der Leitung von Frau Bücker-Kanschik und Frau Jäger kann sich sehen lassen und trägt entscheidend zum starken Fremdsprachenprofil unserer Schule bei.
Außerhalb des Unterrichts bereiten sich zahlreiche Schülerinnen und Schüler der Klassen 7-13 hochmotiviert auf verschiedene Niveaustufen des französischen Sprachdiploms vor. Diese außergewöhnliche Leistung wurde nun auch vom französischen Bildungsministerium gewürdigt, indem über das Institut Français die Plakette „DELF-Partnerschule“ an das MGL verliehen wurde. Félicitations und herzlichen Glückwunsch!
Wer sich auch für das Sprachdiplom DELF interessiert, kann sich an seine Französisch-Lehrkraft oder Frau Bücker-Kanschik direkt wenden. Nach den Sommerferien startet der nächste Durchgang. Allez, macht mit, ihr seid alle herzlich eingeladen!
A. Bücker-Kanschik, 23.05.2023
Erstes regionales MINT-EC-Camp „Die spannende Welt der Insekten“ – 9.-Klässler erzählen begeistert
MINT-EC, das heißt spannende Themen aus Naturwissenschaft, Mathe und Technik erleben. 10 Schulen aus der Region Bonn, Rhein-Sieg und Ahr, so auch das Martinusgymnasium, haben sich zu einem Netzwerk zusammengeschlossen und wollen ihren Schülerinnen und Schülern durch die Zusammenarbeit mehr Erlebnisse bieten. In diesem Rahmen fand vom 25.-27. April das erste gemeinsam organisierte MINT-EC-Camp zum Thema „Insekten“ statt. Die 7 beteiligten Lehrkräfte und 15 Schülerinnen und Schüler der 9. Klassen waren rundum begeistert. Hier folgen nun die Berichte zu den verschiedenen Workshopteilen:
Erstes regionales MINT-EC-Camp „Die spannende Welt der Insekten“ – 9.-Klässler erzählen begeistert

MINT-EC, das heißt spannende Themen aus Naturwissenschaft, Mathe und Technik erleben. 10 Schulen aus der Region Bonn, Rhein-Sieg und Ahr, so auch das Martinusgymnasium, haben sich zu einem Netzwerk zusammengeschlossen und wollen ihren Schülerinnen und Schülern durch die Zusammenarbeit mehr Erlebnisse bieten. In diesem Rahmen fand vom 25.-27. April das erste gemeinsam organisierte MINT-EC-Camp zum Thema „Insekten“ statt. Die 7 beteiligten Lehrkräfte und 15 Schülerinnen und Schüler der 9. Klassen waren rundum begeistert. Hier folgen nun die Berichte zu den verschiedenen Workshopteilen:
Insekten als zukünftiges Nahrungsmittel
(von Maya Kaiser, Ernst-Moritz-Arndt-Gymnasium Bonn)
Am Dienstag, 25.April, um 8:10 Uhr begann der erste Tag des dreitägigen Mint-Camps in der Europaschule in Bornheim. Das Thema: Insekten. Insgesamt haben 15 Schüler*innen von acht Schulen aus Bonn und Umgebung teilgenommen. Was uns vereint: Interesse an Insekten als zukünftiges Nahrungsmittel und ihre Rolle und Relevanz auf der Erde.
Nachdem alle selbstständig oder mit Frau Neumann (Hardtberg Gymnasium) vom Bonner Hauptbahnhof an der Europaschule angekommen waren, ging es in der Lehrküche erstmals zur Sache. Nach kleinen Kennenlernspielen haben wir unseren bisherigen Wissensstand zum Thema Insekten in einer Mindmap gesammelt. Kurz bevor es richtig losging, haben wir uns einen kurzen Film zum Thema Insekten als zukünftiges Nahrungsmittel angeschaut. Danach hatten wir das erste Mal die Möglichkeit, Snacks aus Insekten zuzubereiten (natürlich auch ohne für diejenigen, die die Insekten nicht probieren wollten). Zur Auswahl gab es Insektenchips, Waffeln mit und ohne Mehl der Larven von Buffalowürmern (das sind die, die immer am Getreide knabbern), Pizza mit Mehlwürmern und Grillen als Belag und mit Schokolade überzogene Fruchtspieße mit Heuschrecken (die aufgrund der Offensichtlichkeit des Inhalts die größte Überwindung gekostet haben). Nachdem die Gerichte zubereitet waren, ging es ans Probieren. Obwohl viele erst Scheu vor den Gerichten mit Insekten hatten, haben am Ende fast alle die Gerichte probiert und waren meist auch positiv überrascht.
Das Highlight des Tages: Reporter vom General Anzeiger, Wir Bornheimer und des Schaufensters haben uns interviewt und sich dem Thema Insekten als zukünftiges Nahrungsmittel gewidmet. Noch dabei war eine Mitarbeiterin unseres Sponsors zdi. Weitere finanzielle Unterstützung hatten wir zudem von der Stadt Bonn.
Beim Kochen geholfen haben uns Frau Neumann, Frau Schuhmacher (Europaschule) und eine weitere Lehrkraft der Europaschule. Und wie schmeckt es? Kurz gesagt etwas nussig, doch letztendlich würde man es, wenn man den Inhalt nicht kennen und nicht sehen würde, nicht schmecken. Bloß gut verstecken und ein zukünftiges Nahrungsmittel liegt auf dem Teller.
Link zum Artikel des General Anzeigers
Käfer im Museum König: Die faszinierende Welt der Unscheinbaren
(Ein Bericht von Josefine Jost, Hardtberg-Gymnasium Bonn, und Leonie Heinen, Europaschule Bornheim)
Nachdem wir mit Insekten gestärkt waren, fuhren wir mit der Bahn zum Museum König. Dort angekommen, wurde uns erstmal die Geschichte Alexander Koenigs und des Museums in der Savanne erklärt. Wir bestaunten die dort ausgestellten Tiere, worunter sich auch eine Giraffe befand, die noch von Alexander König selbst ausgestopft worden war. (Ein Stück, was also schon viel erlebt hat.)
Danach ging es in den zweiten Stock, wo wir mehrere Schaukästen anschauen konnten, in denen Insekten und Spinnentiere unterschiedlichster Art untergebracht waren, beispielsweise Libellen und eine Geißelspinne! (Die sieht zwar fies aus, ist aber ganz lieb.)
Als nächstes bekamen wir einen tieferen Einblick in die Sammlung aus ca. 6 Millionen Arten, um die Vielfalt der Käfer zu veranschaulichen. Dabei wurden uns ein paar Käfer gezeigt und besondere Merkmale erklärt.Darauf folgten aber auch Fragen, die sich auf Spinnentiere bezogen, welche im Gegensatz zu den sechsbeinigen Insekten 8 Beine besitzen. Auf diese Weise erfuhren wir von dem motivierten Mitarbeiter des Museums, dass Skorpione mit kleineren Scheren, aber großem Hinterteil oft die giftigeren sind, und bekamen sogar die giftigste Art der Skorpione zu sehen (wenn auch ausgestopft)! Nun lenkte sich das Gespräch mehr auf die manchmal tausendfach bestückten, sehr unterschiedlichen Kokons. Auch mit dem Irrglauben, weibliche Insekten und Spinnentiere würden immer aus reiner Aggressivität nach der Paarung die Männchen fressen, wurde mit dem Beispiel einer ausgestopften Gottesanbeterin aufgeräumt.
Schließlich kam das Gespräch doch wieder zurück auf die Käfer und wir bekamen erklärt, was die Besonderheit an den ebenfalls geflügelten, großäugigen Laufkäfern ist.
Imkern am EMA
(Ein Bericht von Claus Wingenfeld, Hardtberg-Gymnasium Bonn)
Als wir am Mittwoch, den 25. April, dem zweiten Tag unseres MINT-Camps, am Ernst-Moritz-Arndt- Gymnasium eintrafen, mussten wir zuerst diverse Gegenstände rund ums Imkern in drei Kategorien einteilen. Dies geschah jedoch, bevor wir diese Gegenstände und Werkzeuge kennen lernten.
Danach wurden uns diese Gegenstände, Bienen und ihr Verhalten an den Bienen selbst gezeigt. Eines dieser wichtigen Werkzeuge ist zum Beispiel der Smoker. Dieser verbrennt Holz, um Rauch zu erzeugen, der die Bienen beruhigt.
Wieder im Klassenraum angekommen, wurden uns die einzelnen Geräte zur Verarbeitung von Honig gezeigt und auch noch andere Erzeugnisse der Bienen wie zum Beispiel Propolis.
Zum Abschluss durfte dann noch jeder eine Scheibe Brot mit dem schuleigenen Honig essen.
Blüten und ihre Bestäuber im Botanischen Garten
(Ein Bericht von Joudy Aburas, Nicolaus-Cusanus-Gymnasium Bonn, Liana Gensch und Emma Paesler, beide Gymnasium Lohmar)
Am Mittwochnachmittag ging es zum Botanischen Garten in Bonn. Eine nette Dame vom Botanischen Garten führte uns durch die Anlagen und zeigte uns besondere Blüten und ihre Bestäuber. Dabei erzählte sie uns über die Farbe der jeweiligen Blüte, ihr Muster, ihren Nektar, ihren Duft, ihre Blütenform und das Tier, das sie bestäubt. Später untersuchten wir die Blüten unter den Mikroskopen und Lupen und schauten sie uns näher an. Schließlich drehten wir noch eine Runde durch den Botanischen Garten und nahmen Fotos als Erinnerung an diesen schönen Tag auf.
Gegen 15 Uhr beendeten wir unseren Ausflug und nahmen eine Menge neuer, beeindruckender Informationen über Bestäuber und Blüten mit nach Hause.
Blattschneiderameisen und Fauchschaben im Kölner Zoo
(Ein Bericht von Mina Hecken, Franziska Jodl und Anneke Moll, Martinus-Gymnasium Linz)
Am Donnerstag, den 26.04., unserem letzten Tag, besuchten wir den Kölner Zoo.
Als erstes wurden wir in der Zooschule empfangen und uns wurden Arbeitsblätter über den tropischen Regenwald ausgeteilt. Um diese auszufüllen, gingen wir ins Tropenhaus. Der Temperaturunterschied zwischen deutschem und tropischem Frühling war beeindruckend und natürlich auch die Vegetation. Dort konnten wir durch Fragen und Betrachten viel über den Äquator lernen, besser als man es im normalen Unterricht hätte tun können.
Nach dem Besuch im Tropenhaus beschäftigten wir uns in Gruppen mit verschiedenen Aufgaben über Blattschneiderameisen, wobei wir auch die Möglichkeit hatten, uns eine lebendige Blattschneiderameisenkolonie anzusehen. Am Schluss präsentierten wir uns gegenseitig die Ergebnisse.
In der Pause kauften wir uns dann vegetarisches Essen im Zoorestaurant. Nach der Pause ging es mit Versuchen an Fauchschaben weiter, deren Fähigkeiten wir mit verschiedenen Methoden testeten. Auch wenn sich manche vor den Schaben ein bisschen gruselten, fanden wir trotzdem viele interessante Dinge über sie heraus, zum Beispiel, dass sie sich schnell an Reize gewöhnen.
Am Ende des Insekten-Camps beantworteten wir noch ein Quiz als Rückmeldung über die Camp-Tage und bekamen dann schließlich noch Teilnehmerurkunden. Viele Teilnehmer blieben noch nach dem Ende des MINT-EC-Camps im Zoo, um die Tiere anzuschauen und Spaß zu haben.
H. Meixner, 15.05.23
![]() |
![]() |
![]() |
![]() |
Känguru der Mathematik am MGL
Wenn sich Biber und Kängurus im Kreis aufstellen, Martha mit hellen und dunklen Bauklötzen spielt, Nick versucht, Wasser zu sparen und jemand im Badezimmerspiegel auf die Uhr schaut, dann sind wir wieder mittendrin in den spannenden Aufgaben des „Kängurus der Mathematik“!
Känguru der Mathematik am MGL

Wenn sich Biber und Kängurus im Kreis aufstellen, Martha mit hellen und dunklen Bauklötzen spielt, Nick versucht, Wasser zu sparen und jemand im Badezimmerspiegel auf die Uhr schaut, dann sind wir wieder mittendrin in den spannenden Aufgaben des „Kängurus der Mathematik“!
Dem diesjährigen Wettbewerb rund um mathematische Knobeleien stellten sich 63 eifrige Schülerinnen und Schüler des MGL am 16. März 2023 – damit waren sie in guter Gesellschaft, denn deutschlandweit gab es über 800.000 Teilnehmende.
Jetzt erhielten alle ihre Urkunde, ein Insel-Spiel als „Preis für alle“ und eine Broschüre mit den Lösungen samt Erläuterungen. Die Stufensiegerinnen und Sieger wurden besonders ausgezeichnet (siehe Bild): Benjamin Zeichner (5a), Harun Kedikoglu (6a), Emma Born (7c), Ly Nguyen (8b), Julian Richarz (9a), Teodor Gabel (10a), Benedikt Jagau (MSS 12). Harun und Emma konnten sogar einen 2. Preis erringen und wurden mit einem Buch bzw. einem Spiel belohnt. Dabei gelang Harun zusätzlich der weiteste „Kängurusprung“ – er beantwortete 12 aufeinanderfolgende Fragen richtig!
Für das am MGL neu eingeführte MINT-Zertifikat des Landes Rheinland-Pfalz sind durch die Teilnahme am Känguru-Wettbewerb schon erste Sternchen errungen worden. Weiter so!
L. Tironi, 14.05.2023
![]() |
Erfolg bei „Jugend forscht“ 2023
„Welches ist wohl das beste Desinfektionsmittel?“ – diese Frage hat sich Hannah Ohly im Verlauf der Corona-Pandemie immer wieder gestellt. Grund genug, dieser Fragestellung einmal wissenschaftlich auf den Grund zu gehen. So kam sie auf die Idee, eine Arbeit für den Wettbewerb Jugend forscht / Schüler experimentieren anzufertigen.
Erfolg bei „Jugend forscht“ 2023
„Welches ist wohl das beste Desinfektionsmittel?“ – diese Frage hat sich Hannah Ohly im Verlauf der Corona-Pandemie immer wieder gestellt. Grund genug, dieser Fragestellung einmal wissenschaftlich auf den Grund zu gehen. So kam sie auf die Idee, eine Arbeit für den Wettbewerb Jugend forscht / Schüler experimentieren anzufertigen.
Dazu musste sie zunächst einmal die Kriterien festlegen, die sie untersuchen wollte: Sie wollte den Preis, die Hautverträglichkeit und den Duft der verschiedenen Mittel vergleichen. Am wichtigsten jedoch war ihr die Fragestellung: Wie wirksam sind die Mittel?
Dazu entwickelte Hannah ein funktionierendes Verfahren: Auf einer Agar-Petrischale zog sie Kolonien von Joghurt-Bakterien und Hefepilzen an. Außerdem legte sie Papierplättchen auf die Platten, die zuvor mit Desinfektionsmitteln getränkt wurden. All diese Arbeitsschritte musste sie unter möglichst sterilen Bedingungen durchführen.

Rund um die Plättchen bildete sich nun ein Hemmhof, in dem kein Bakterien- oder Pilzwachstum möglich war, wenn das entsprechende Desinfektionsmittel wirksam war. Abhängig von der Größe dieses Hemmhofs konnte Hannah den Grad der Wirksamkeit von verschiedenen Desinfektionsmitteln untersuchen und vergleichen.
Alle ihre Ergebnisse stellte sie beim diesjährigen Regionalwettbewerb Remagen von Jugend forscht / Schüler experimentieren vor und überzeugte die Jury durch eine sehr gelungene Präsentation ihrer Arbeit. Diese schrieb in ihrer Laudatio:
„Wir möchten Dir zu Deiner exzellenten Experimentierarbeit gratulieren und Dir ein hervorragendes Feedback geben. Es ist wirklich beeindruckend zu sehen, wie du eine eigene Versuchsreihe aufgebaut hast und dass Du Deine guten Ideen in die Realität umgesetzt hast. Deine Selbstständigkeit und Dein Engagement zeigen Dein starkes Interesse an diesem Thema. Du hast Dich in mikrobiologische Arbeitsweisen tiefgehend eingearbeitet.
Deine Sorgfalt bei der Durchführung des Experiments und die Gründlichkeit, mit der Du Deine Ergebnisse dokumentiert hast, sind besonders bemerkenswert.
Dank Deiner Versuchsergebnisse wissen wir nun, welches Handdesinfektionsmittel wir in Zukunft verwenden werden.“
Hannah wurde für ihre Arbeit mit dem Regionalsieg im Arbeitsgebiet Biologie belohnt und durfte im April nun beim Landeswettbewerb Schüler Experimentieren antreten, der von Boehringer Ingelheim ausgerichtet wurde.

Von diesem Wettbewerb berichtet sie sehr begeistert:
„Während meines Aufenthaltes beim Landeswettbewerb habe ich viele tolle Menschenkennengelernt. Die interessanten Projekte, die alle sehr unterschiedlich waren, haben mir auch Inspiration für die Zukunft gegeben. Nachmittags gab es eine tolle Show von einem Artisten. Nach der Preisverleihung trat eine Gruppe afrikanischer Trommler auf, die auch an die Zuschauer Trommeln verteilten. Unter ihrer Führung trommelten wir dann alle gemeinsam. Das hat viel Spaß gemacht.
Vor der Preisverleihung haben wir Jungforscherinnen und Jungforscher noch ein Jobangebot für später von Boehringer Ingelheim erhalten. Die meisten Kosten wurden übernommen wie z.B. die Unterkunft. Die Jugendherberge, in der wir untergebracht wurden, war sehr schön und hatte einen guten Ausblick auf den Rhein. Dazu kommt noch, dass es kleine Geschenke für jeden gab, selbst für die Projektbetreuer. Die Preise waren sehr großzügig.
Insgesamt war es ein tolles Erlebnis und ich freue mich auf das nächste Mal.“
Hannahs Arbeit wurde auch auf dem Landeswettbewerb mit einem Sonderpreis ausgezeichnet!
Herzlichen Glückwunsch!

Gemeinsames Projekt „Märchen“ in den Fächern Kunst und Deutsch der Klassen 5b und 5d
Das Thema „Märchen“ ist eine wunderbare Möglichkeit, fachübergreifend zu arbeiten und wurde dieses Schuljahr in zwei der 5. Klassen genutzt, um die Fächer Kunst und Deutsch zu verbinden.
Durchgeführt wurde das Projekt von den Deutschlehrerinnen der Klassen 5b und 5d (Ursula Roos, Barbara Deppe) gemeinsam mit der Kunstlehrerin beider Klassen (Elena Böyer).
In Gruppen von jeweils 3-5 Schülern wurde im Kunstunterricht eine Theaterbühne gebaut und im Deutschunterricht ein dazu passendes Märchen geschrieben. Am Ende haben die Gruppen ihr eigenes Märchen auf der selbstgebauten Bühne zur Aufführung gebracht.
Gemeinsames Projekt „Märchen“ in den Fächern Kunst und Deutsch der Klassen 5b und 5d
Das Thema „Märchen“ ist eine wunderbare Möglichkeit, fachübergreifend zu arbeiten und wurde dieses Schuljahr in zwei der 5. Klassen genutzt, um die Fächer Kunst und Deutsch zu verbinden.
Durchgeführt wurde das Projekt von den Deutschlehrerinnen der Klassen 5b und 5d (Ursula Roos, Barbara Deppe) gemeinsam mit der Kunstlehrerin beider Klassen (Elena Böyer).
In Gruppen von jeweils 3-5 Schülern wurde im Kunstunterricht eine Theaterbühne gebaut und im Deutschunterricht ein dazu passendes Märchen geschrieben. Am Ende haben die Gruppen ihr eigenes Märchen auf der selbstgebauten Bühne zur Aufführung gebracht.
Zur Vorbereitung fuhren beide Klassen nach Bonn zur Bundeskunsthalle um die Ausstellung „Die Oper ist tot, es lebe die Oper“ zu besuchen. Dies wurde mit der Teilnahme am Workshop „Mise en Scène“ verbunden. Dort konnten die Schüler und Schülerinnen viele schöne Inspirationen für die Gestaltung einer Bühne sammeln.
In den nächsten Wochen gingen die Künstler beider Klassen eifrig ans Werk. Es wurden im Kunstunterricht Bühnen aus Schuhkartons sowie passende Figuren gezaubert und im Deutschunterricht magische Märchen gedichtet. Anschließend haben die Klassen viel geprobt, um eine tolle Aufführung der Märchen auf den Bühnen zu bieten.
Hierfür waren wirklich alle Kinder mit unglaublicher Begeisterung und viel Ehrgeiz am Werk.
So hatte dann die Klasse 5b am 31.03. kurz vor den Osterferien ihre Aufführung in der Bibliothek unserer Schule und Klasse 5d war als Zuschauer zu Gast. Am 12.04. kam es zum „Rückspiel“, nun präsentierte die 5d ihre Märchen auf den selbstgebauten Bühnen und die 5b konnte zuschauen. Aufgelockert durch Quizfragen zum Thema Märchen wurden bei Vorstellungen ein großer Erfolg und haben den Kindern, aber auch den Lehrerinnen und Gästen, viel Freude bereitet.
Im abschließenden „Brainstorming“ tauschten sich dann die Klassen und die Lehrerinnen darüber aus, was gut gelaufen war und wo es vielleicht noch Möglichkeiten zur Verbesserung gab. Insgesamt ein tolles und lehrreiches Projekt, bei dem die Schülerinnen und Schüler ihre ganze Kreativität sowohl künstlerisch wie auch sprachlich ausleben konnten.
Abitur 2023
Das Martinus-Gymnasium verabschiedet seinen diesjährigen Abiturjahrgang.
Abitur 2023
Bei der Abiturfeier des Martinus-Gymnasiums Linz feierten 66 Schülerinnen und Schüler ihren Abschluss. Schulleiter Thomas Schmacke gratulierte herzlich und gab ihnen Worte der Poetry Slammerin Julia Engelmann mit auf den Weg: „Also los, schreiben wir Geschichten / die wir später gern erzählen!“. Eine besondere Freude für die Schulgemeinschaft ist, dass alle, die die MSS 13 begonnen hatten, nun auch erfolgreich das Abitur bestanden haben. 21 Schülerinnen und Schüler haben sogar eine 1 vor dem Komma erreicht. Die fünf besten Absolventen mit der Gesamtnote „sehr gut“ sind Leonie Richarz, Rachel Fischer, Nina Küpper, Eva Lindner, Sebastian Bensch, Carolina Corvinus, Gabriel Szczepanski und Florian Velling. Mit dem Preis der Bildungsministerin Stefanie Hubig für vorbildliche Haltung und beispielhaften Einsatz in der Schule wurde Florian Augst ausgezeichnet.
„Als Kind bin ich in einer heilen Welt aufgewachsen." - Großwerden in der Deutschen Demokratischen Republik
Wie war es, in der DDR aufzuwachsen? Diese Frage stellten Schüler*innen der 10C im letzten Schuljahr ihren in der DDR aufgewachsenen Eltern und Verwandten.
Herausgekommen ist dabei ein Podcast, der über die unterschiedlichsten Themen des Alltags berichtet und dabei auch Zeitzeug*innen zu Wort kommen lässt.
„Als Kind bin ich in einer heilen Welt aufgewachsen." - Großwerden in der Deutschen Demokratischen Republik

Ein Podcast von Emily Mielke, Ben Reimann, Nora Riemann und Inken Thieme (11. Stufe)
Wie war es, in der DDR aufzuwachsen?
Diese Frage stellten Schüler*innen der 10C im letzten Schuljahr ihren in der DDR aufgewachsenen Eltern und Verwandten.
Herausgekommen ist dabei ein Podcast, der über die unterschiedlichsten Themen des Alltags berichtet und dabei auch Zeitzeug*innen zu Wort kommen lässt.
Schule, Militärdienst, Hobbys … Und wer waren eigentlich die Jungen Pioniere?
Die Berichte der Zeitzeug*innen machen deutlich, wie viel „heile Welt“ möglich war, aber auch wie viele Einschränkungen und Verbote existierten.
B. Deppe, 15.3.23
SOS Rosarno: Zitrusfrüchte ohne Ausbeutung und ohne Gift
Im Januar hat das MGL zusammen mit dem Eine Welt Laden Linz an einer biofairen Zitrusfrüchte-Aktion teilgenommen. Es konnten frischgeerntete Orangen, Mandarinen und Zitronen über die Nachhaltigkeits-AG bestellt werden. Diese Früchte werden ohne Pestizide angebaut und weder begast noch gewachst. Gleichzeitig stellt der von Aktivisten, Landwirten und Migranten in Kalabrien gegründete Verein sicher, dass die Arbeiter reguläre Arbeitsverträge und faire Löhne erhalten.
SOS Rosarno: Zitrusfrüchte ohne Ausbeutung und ohne Gift

Im Januar hat das MGL zusammen mit dem Eine Welt Laden Linz an einer biofairen Zitrusfrüchte-Aktion teilgenommen. Es konnten frischgeerntete Orangen, Mandarinen und Zitronen über die Nachhaltigkeits-AG bestellt werden. Diese Früchte werden ohne Pestizide angebaut und weder begast noch gewachst. Gleichzeitig stellt der von Aktivisten, Landwirten und Migranten in Kalabrien gegründete Verein sicher, dass die Arbeiter reguläre Arbeitsverträge und faire Löhne erhalten.
Mit dem Verkauf der Früchte wird auch die Hilfsorganisation „Mediterranean Hope“, die sich u.a. um menschenwürdige Unterkünfte für die Erntehelfer kümmert, unterstützt.
Die Idee, SOS Rosarno zu unterstützen, entstand durch einen persönlichen Kontakt. Wir haben uns sehr gefreut, dass wir über 50 Bestellungen aufnehmen konnten und die Zufriedenheit mit der Qualität der Früchte sehr groß war.
Das motiviert uns, die Aktion zu Beginn der nächsten Zitrusfrüchte-Saison zu wiederholen!
C. Schardinel-Wassong, S. Hanke, 14.3.23
Für alle, die mehr wissen wollen: Hier finden sich Informationen über Hintergründe und Anliegen der Zitrusfrüchte-Aktion:
der Situation der Arbeiter auf den Orangenplantagen
sowie die Arbeit von SOS Rosarno, Mediterranean Hope und anderen Alternativen
![]() |
![]() |
Erfolgreiche Teilnahme am Planspiel Börse 2022 – MGL-Team belegt Platz 3.
Auch im vergangenen Jahr meldeten sich wieder zahlreiche Schüler*innen des Martinus-Gymnasiums zur Teilnahme am Planspiel Börse der Sparkassen an.
Erfolgreiche Teilnahme am Planspiel Börse 2022 – MGL-Team belegt Platz 3.

Auch im vergangenen Jahr meldeten sich wieder zahlreiche Schüler*innen des Martinus-Gymnasiums zur Teilnahme am Planspiel Börse der Sparkassen an.
Zunächst mussten sich die Schüler*innen ab dem 08.09.2022 zu Teams zusammenschließen. Ab dem 04.10.2022 konnte dann offiziell der Aktienhandel gestartet werden. Dabei erhielt jedes Team ein Depot in Höhe von 50.000 Euro. Während der sogenannten Tradingphase war es jetzt Aufgabe der jeweiligen Teams, möglichst sinnvolle Entscheidungen im Hinblick auf Märkte und Unternehmen zu tätigen. Der Aktienhandel selbst lief dabei in Echtzeit – parallel zur Wirklichkeit – ab, Aktienkurse wurden real abgebildet. Der letzte Handelstag war der 31.01.2023.
Das Team “BELFORTESS“ belegte nach der Endabrechnung den Platz drei unter 78 Teams im Kreis im Bereich der Nachhaltigkeitswertung mit einem Plus von 2458,08 Euro.
Die Betreuer*innen der Sparkasse Neuwied sowie die Fachschaft Sozialkunde gratulieren wie immer zur erfolgreichen Teilnahme und Platzierung am Planspiel Börse 2022/ 23. Das Preisgeld betrug in diesem Fall 50 Euro für das Team.
J. Ruhnau, 13.3.23 (Fachschaft Sozialkunde)
Musicalfahrt Hamburg
Wir, die Musical-AG und die Big Band des Martinus-Gymnasiums Linz, fuhren vom 22.02.2023 bis 24.02.2023 nach Hamburg. Wir übernachteten für zwei Nächte in einer Jugendherberge und schauten uns in dieser Zeit zwei Musicals an.
Musicalfahrt Hamburg

Wir, die Musical-AG und die Big Band des Martinus-Gymnasiums Linz, fuhren vom 22.02.2023 bis 24.02.2023 nach Hamburg. Wir übernachteten für zwei Nächte in einer Jugendherberge und schauten uns in dieser Zeit zwei Musicals an.
Am ersten Abend konnten wir uns aussuchen, ob wir das Musical „Mamma Mia“ oder „König der Löwen“ besuchen wollen. Nach den beeindruckenden Musicals trafen wir uns in einem Restaurant zum gemeinsamen Essen, allerdings war hier der Abend noch lange nicht vorbei. Bis tief in die Nacht spielten wir in dem Aufenthaltsraum unserer Jugendherberge „Werwolf“, aßen Snacks und lachten viel, was nochmals den Zusammenhalt unserer Gruppe stärkte, außerdem gab es uns die Gelegenheit, uns untereinander nochmal besser kennenzulernen.
Todmüde kamen die meisten morgens zum Frühstück, doch der Abend hatte sich definitiv gelohnt. Danach hatten wir etwas Freizeit, z.B. erkundeten einige Hamburg oder manch andere arbeiteten mit Herrn Lehmann an ihren Rollen für unser neues Musical, bevor wir uns auf den Weg zum Lasertag machten. Beim Lasertag herrschte eine aufregende Stimmung, denn bei vielen Duellen war es ein Kopf-an-Kopf-Rennen. Am zweiten Abend schauten wir das Musical „Hamilton“ an, was der Höhepunkt unserer Fahrt war, da dieses wirklich ein Meisterwerk ist, vor allem das sehenswerte Bühnenbild und die faszinierenden Schauspieler.
Insgesamt hat uns der Aufenthalt in Hamburg genauso gut gefallen wie letztes Jahr die Fahrt in diese tolle Stadt, deswegen möchte wir uns auch ganz herzlich bei Frau Beissel und Herrn Lehmann bedanken, dass sie dies möglich machen konnten.
Der Trip nach Hamburg war für uns alle eine großartige Erfahrung und wir freuen uns auf weitere schöne Erlebnisse.
N. Riemann, 10.3.23
![]() |
![]() |
![]() |
Bundeskanzler Olaf Scholz am Breathe2Change Projekt interessiert
Das Breathe2Change Projekt, in dessen Rahmen das MGL auch eine Luftqualitätsmessstation betreibt, findet große Aufmerksamkeit. Der Leiter des Projekts, Dr. Rodrigo Gilibisco, ein ehemaliger Humboldt-Stipendiat und Kollege von Dr. Ralf Kurtenbach von der Bergischen Universität Wuppertal,ist derzeit zurück in Argentinien (Tucuman) und hatte vor wenigen Tage die Gelegenheit, das Projekt dem deutschen Bundeskanzler Olaf Scholz vorzustellen, der im Rahmen seiner Südamerikareise auch Halt in Argentinien machte.
Bundeskanzler Olaf Scholz am Breathe2Change Projekt interessiert

Das Breathe2Change Projekt, in dessen Rahmen das MGL auch eine Luftqualitätsmessstation betreibt, findet große Aufmerksamkeit. Der Leiter des Projekts, Dr. Rodrigo Gilibisco, ein ehemaliger Humboldt-Stipendiat und Kollege von Dr. Ralf Kurtenbach von der Bergischen Universität Wuppertal,ist derzeit zurück in Argentinien (Tucuman) und hatte vor wenigen Tage die Gelegenheit, das Projekt dem deutschen Bundeskanzler Olaf Scholz vorzustellen, der im Rahmen seiner Südamerikareise auch Halt in Argentinien machte.
„Wir sind froh, dass das MGL an dem Projekt beteiligt ist und so zur Verbesserung der Luftqualität beiträgt“, so Dr. Söhl und Dr. Kurtenbach.
Die Messwerte für Feinstaub wie die Massen- (PM) und die Partikelanzahlkonzentration (NP), Kohlendioxid (CO2) sowie meteorologische Messwerte wie Temperatur, Luftdruck und relative Feuchte der Messstation in der Einfahrt des MGL sind unter folgenden Internetadresse veröffentlicht: http://breathe2change.roblelab.com.ar/map
Wer allgemein mehr über das Projekt erfahren möchte, der möge sich unter der folgenden Internetadresse informieren: https://www.neuerweg-group.com/
G. Söhl, 9.3.23
Aus dem Unterricht: Mathe-LK bringt die analytische Geometrie auf den Schulhof
Vom Beobachtungspunkt aus erscheint der Schriftzug „ABI23“ in 3D – von allen anderen Stellen auf dem Schulhof sieht man nur verzerrte Kreidestriche.
Aus dem Unterricht: Mathe-LK bringt die analytische Geometrie auf den Schulhof

Vom Beobachtungspunkt aus erscheint der Schriftzug „ABI23“ in 3D – von allen anderen Stellen auf dem Schulhof sieht man nur verzerrte Kreidestriche.
Der 13er-Mathe-LK hat daran die ganze Woche gefeilt: Zunächst wurde der Schriftzug entworfen und in ein dreidimensionales Koordinatensystem übertragen. Dann folgte die Berechnung: Die einzelnen Eckpunkte mussten in die x1x2-Ebene projiziert werden. Schließlich konnten die Ergebnisse mit viel Straßenkreide auf den Schulhof übertragen werden.
L. Tironi, 2.3.23
![]() |
![]() |
![]() |
„Jeder kann sich politisch gegen Rechtsextremismus engagieren ! “
Ehemaliger Neonazi hält Vortrag am Martinus-Gymnasium Linz zum Thema Rechtsextremismus
Am 07.02.2023 besuchte der ehemalige Neonazi und heutige Bildungsreferent zum Thema Rechtsextremismus Christian Weißgerber im Rahmen einer politischen Informationsveranstaltung zum Thema Rechtsextremismus das Martinus-Gymnasium Linz.
Von 10 bis 13 Uhr berichtete er den Schülerinnen und Schülern der Jahrgangsstufen 11 bis 13 über seine Erfahrungen in der rechten Szene und erzählte auch anhand seiner Person, welche Faktoren dazu führen können, dass man sich radikalisiert und Nazi wird.
„Jeder kann sich politisch gegen Rechtsextremismus engagieren ! “

Ehemaliger Neonazi hält Vortrag am Martinus-Gymnasium Linz zum Thema Rechtsextremismus
Am 07.02.2023 besuchte der ehemalige Neonazi und heutige Bildungsreferent zum Thema Rechtsextremismus Christian Weißgerber im Rahmen einer politischen Informationsveranstaltung zum Thema Rechtsextremismus das Martinus-Gymnasium Linz.
Von 10 bis 13 Uhr berichtete er den Schülerinnen und Schülern der Jahrgangsstufen 11 bis 13 über seine Erfahrungen in der rechten Szene und erzählte auch anhand seiner Person, welche Faktoren dazu führen können, dass man sich radikalisiert und Nazi wird. Neben der persönlichen Lebenssituation innerhalb der Familie waren das bei ihm vor allem auch sein Wohnort Eisenach in Thüringen und die Vorstellung, die im Unterricht beigebrachte Geschichte kritisch zu hinterfragen und auch nach Alternativen zu suchen. Auch Musik und Freunde spielten bei seiner Radikalisierung und seinem Einstieg in die rechtsextreme Szene eine große Rolle.
Nachdem Christian Weißgerber den Schülerinnen und Schülern über eine Stunde viele wichtige und interessante Informationen zu diesem Thema anschaulich nähergebracht hatte, hatten diese in einer „Murmelphase“ die Möglichkeit, sich über das Erfahrene auszutauschen und kurz Pause zu machen. Anschließend durften sie ihre Fragen an den Referenten stellen, welcher sie gerne beantwortete. Einige der Fragen bezogen sich z.B. darauf, ob er heute rückblickend etwas anders gemacht hätte, wie man eine mögliche nationalsozialistische Gesinnung bei einem Gesprächspartner erkennen kann und wie man sich gegen Rechtsextremismus engagieren kann. „Es gibt sehr viele verschiedene Arten, sich politisch gegen Rechtsextremismus zu engagieren, sei es in einer Partei, auf Demos oder in Bürgerinitiativen, das muss jeder für sich selbst entscheiden,“ erklärte er.
Anschließend berichtete Christian Weißgerber dem interessierten Publikum auch über seinen Ausstieg aus dem Rechtsextremismus, welche Folgen dieser hatte und warum es insgesamt so wenige Aussteiger aus extremistischen Bewegungen wie dem Rechtsextremismus gibt. Gegen Ende fasste er seinen Vortrag in wenigen Punkten zusammen und gab den Schülerinnen und Schülern auch einige Ratschläge und wichtige Informationen fürs Leben mit auf den Weg. Zum Abschluss der Veranstaltung richtete der Schulleiter Thomas Schmacke, welcher gemeinsam mit dem ehemaligen Schülervertreter Florian Augst die Veranstaltung organisiert hatte, ein paar Worte an die versammelten Schüler: „Ich finde es toll, dass wir hier heute so eine informative und interessante Veranstaltung organisieren konnten, die unseren Schülerinnen und Schülern das Thema Rechtsextremismus nähergebracht und viel zur politischen Bildung am Martinus-Gymnasium beigetragen hat.“
Möglich wurde diese Veranstaltung zudem durch die Unterstützung des Fördervereins des Martinus-Gymnasiums Linz , der Volksbank Linz-Neuwied eG und der Sparkasse Linz. Auch die Landtagsabgeordnete Ellen Demuth und der Bundestagsabgeordnete Martin Diedenhofen haben das Martinus-Gymnasium bei der Suche nach Fördermitteln unterstützt.
Der Sozialkunde-LK 13 fährt nach Straßburg und lernt Europa kennen
…Strasbourg. Ein Ort, an dem alle europäischen Mitgliedstaaten aufeinandertreffen.
Der Leistungskurs Sozialkunde durfte in Begleitung von Frau Nefigmann
und Frau Deppe von Montag, dem 13.02.2013 bis Mittwoch, dem 15.02.2023
die wunderschöne Stadt, die geprägt ist von deutscher und französischer
Kultur, kennen und lieben lernen.
Es ist nicht nur unsere dritte Fahrt mit Frau Nefigmann zusammen, sondern auch die letzte Kursfahrt als Gemeinschaft.
Der Sozialkunde-LK 13 fährt nach Straßburg und lernt Europa kennen

…Strasbourg. Ein Ort, an dem alle europäischen Mitgliedstaaten aufeinandertreffen.
Der Leistungskurs Sozialkunde durfte in Begleitung von Frau Nefigmann und Frau Deppe von Montag, dem 13.02.2013 bis Mittwoch, dem 15.02.2023 die wunderschöne Stadt, die geprägt ist von deutscher und französischer Kultur, kennen und lieben lernen.
Es ist nicht nur unsere dritte Fahrt mit Frau Nefigmann zusammen, sondern auch die letzte Kursfahrt als Gemeinschaft.
Nach der vierstündigen Zugfahrt galt es zunächst den ÖPNV in Frankreich zu verstehen… Mit dem Bus ging es schließlich ins Hotel „Ciarus“. Dort angekommen studierten wir natürlich ausgiebig die Hausordnung, um auch haargenau zu wissen, welche Grenzen es gibt. An diese wollten wir uns schließlich vorbildlich halten. Nach dem kräftigenden 3-Gänge-Abendessen ging es für uns in den Gemeinschaftsraum. Während 8 Jungs & ihre Trainerinnen fleißig am Männerballett für den Broadway schliffen, verbrachten die anderen noch ein paar gemütliche Stunden innerhalb und außerhalb unserer Unterkunft.
Am Dienstag kamen wir unserem Bildungsauftrag nach.
Um 10 Uhr brachen wir zum Europäischen Parlament auf. In diesem sitzen direkt gewählte Abgeordnete, die für die Repräsentation & die Interaktion mit den EU-Bürgern verantwortlich sind. Auch bei der Verabschiedung von Gesetzen spielen sie eine große Rolle, wie wir in der Abstimmung, der wir beiwohnten, miterleben durften. Abstimmungen über Gesetzesvorschläge und -änderungen werden innerhalb weniger Minuten mit Handzeichen oder einer namentlichen Abfragung beschlossen. Für uns sah das alles erst einmal unüberschaubar und chaotisch aus. Sobald die Abstimmung vorbei war, war der große Plenarsaal binnen weniger Minuten wie leer gefegt. Und das, obwohl es nun um das „Istanbuler Abkommen“ ging, mit Hilfe dessen die Gewalt gegen Frauen eingedämmt werden soll.
Auch für uns ging es weiter…
Wir hatten nun die Gelegenheit, mit zwei Parlamentsabgeordneten zu sprechen.
Anna Deparnay-Grunenberg und Karsten Lucke brachten Licht ins Dunkle und entwirrten für uns die komplizierten Prozesse und die Kompetenzen des Europaparlaments. Wir erfuhren, wie die beiden zu ihrem Beruf kamen, wie komplex die Arbeit innerhalb der Ausschüsse ist und wie unterschiedlich unser Bundesparlament gegenüber dem europäischen Parlament arbeitet.
Anschließend besuchten noch das Parlamentarium, in dem uns gezeigt wurde, welch großen und positiven Einfluss die Europapolitik auf die Weltpolitik hat und wie durch die Zusammenarbeit der 27 Mitgliedsstaaten ein Miteinander verwirklicht werden kann.
Unseren letzten Tag in Straßburg verbrachten wir im Europaviertel.
Hier absolvierten wir eine Schnitzeljagd rund um die europäischen Institutionen. Bei Sonnenschein ging es am Spätnachmittag mit pünktlichen Zügen zurück nach Hause.
Wir danken der Staatskanzlei und dem Bildungsministerium in Mainz für die großzügige Unterstützung der Fahrt. Es hat sich gelohnt!
K. Bösche, 28.2.23
![]() |
![]() |
Närrische Zeit am MGL
Die Bläserklassen und die Konzertband erlebten an Karneval ein exklusives Konzert der Linzer Gruppe „Blechjedöns“. Angeführt von Herrn Arz spielten die sieben Musiker Karnevals- und Party-Hits.
Närrische Zeit am MGL

Die Bläserklassen und die Konzertband erlebten an Karneval ein exklusives Konzert der Linzer Gruppe „Blechjedöns“. Angeführt von Herrn Arz spielten die sieben Musiker Karnevals- und Party-Hits.
So kam Stimmung im vollbesetzten Musiksaal auf und die Schülerinnen und Schüler der Bläserklasse konnten sich direkt ein potenzielles Ensemble für die eigene musikalische Zukunft anhören.

Bereits jetzt besteht „Blechjedöns“ zum überwiegenden Teil aus Schülern des MGL.
In den nächsten Tagen ist „Blechjedöns“ noch auf verschiedenen Karnevalsveranstaltungen in und um Linz zu hören!
T. Lehmann
Geschichte hautnah: 17 neue Stolpersteine in Linz verlegt
Nachdem der Künstler Gunter Demnig bereits ein Jahr zuvor 12 Stolpersteine in Gedenken an die Opfer des Nationalsozialismus verlegt hatte, wurden am Donnerstag, den 2. Februar 2023 17 weitere Stolpersteine in Linz am Rhein verlegt. Diesem besonderen Ereignis wohnten die Schülerinnen und Schüler der Klasse 10c von Frau Meurer bei.
Geschichte hautnah: 17 neue Stolpersteine in Linz verlegt

Nachdem der Künstler Gunter Demnig bereits ein Jahr zuvor 12 Stolpersteine in Gedenken an die Opfer des Nationalsozialismus verlegt hatte, wurden am Donnerstag, den 2. Februar 2023 17 weitere Stolpersteine in Linz am Rhein verlegt.
Diesem besonderen Ereignis wohnten die Schülerinnen und Schüler der Klasse 10c von Frau Meurer bei. Im Zuge der feierlichen Verlegung der Stolpersteine erfuhren sie u.a., dass eines der Opfer, Fritz Meyer (geb. 1894) das Linzer Gymnasium besucht hat und aktives Mitglied des örtlichen Turnvereins war, bevor er wenig später nach Köln zog und von dort aus nach Theresienstadt und später nach Auschwitz deportiert wurde, wo er ermordet wurde. Ein Junge wie du und ich…
Die neu verlegten Stolpersteine findet man am Leetor 20 und 22, sowie in der Mittelstraße 17. Damit wird an die Menschen aus Linz am Rhein erinnert, die Opfer des nationalsozialistischen Regimesgeworden sind.
Wer nähere Informationen zu den Stolpersteinen in Linz haben möchte, wird auf der Seite des Stadtarchivs fündig: https://www.stadtarchiv.linz.de/stolpersteine
S. Meurer
![]() |
![]() |
![]() |
![]() |
Schachteam der Jahrgangsstufen 5 und 6 des MGL erringt Rang 1 im Regionalentscheid des Schulschachwettbewerbs 2023
Angespannte Stille – nur das Ticken der Schachuhren ist zu hören – ab und zu hört man jemanden „Schach“ oder „J'adoube“ sagen, sonst hört man nur das leise Tuscheln der Kiebitze im Zuschauerbereich.
Zwei Teams – insgesamt eine Schachspielerin und zehn Schachspieler des MGL – traten am Samstag, 28.1.23 im Regionalentscheid des diesjährigen Schulschachwettbewerbs in Bendorf gegen die besten Teams anderer Schulen aus dem Bereich Koblenz an. Für viele war es die erste Turniererfahrung ihres Lebens - und was für eine!
Schachteam der Jahrgangsstufen 5 und 6 des MGL erringt Rang 1 im Regionalentscheid des Schulschachwettbewerbs 2023

Angespannte Stille – nur das Ticken der Schachuhren ist zu hören – ab und zu hört man jemanden „Schach“ oder „J'adoube“ sagen, sonst hört man nur das leise Tuscheln der Kiebitze im Zuschauerbereich.
Zwei Teams – insgesamt eine Schachspielerin und zehn Schachspieler des MGL – traten am Samstag, 28.1.23 im Regionalentscheid des diesjährigen Schulschachwettbewerbs in Bendorf gegen die besten Teams anderer Schulen aus dem Bereich Koblenz an. Für viele war es die erste Turniererfahrung ihres Lebens - und was für eine!

Während das Team der Wettkampfklasse II, bestehend aus Anneke, Daniel, Julian, Leon, Quang-Binh und Tim, nach einem überzeugenden Erfolg in der ersten Runde im Fortgang des Turniers angesichts sehr starker Gegner leider deutlich Federn lassen musste, gelang dem Team der Wettkampfklasse III geradezu ein Durchmarsch: Caner, Darius D., Darius Z., Harun und Samuel konnten sich in jeder Paarung durchsetzen und errangen in einer überzeugenden Teamleistung mit insgesamt 13 von 16 möglichen Brettpunkten einen souveränen ersten Platz, wobei dies nicht ganz einfach war, wie z.B. Samuel fand: „Ich war sehr nervös, denn die Gegner wurden von Runde zu Runde immer schwieriger.“ Ergänzend dazu Haruns Fazit: „Wir haben alles gegeben und haben verdient gewonnen!“
Sie qualifizierten sich durch den Sieg im Bezirksentscheid Koblenz für die nächste Runde und fahren am 8. März 2023 nach Trier zum Landesentscheid in ihrer Wettkampfklasse III. Wir drücken die Daumen und wünschen viel Erfolg!
Doch auch das Team der Wettkampfklasse II darf mit einem respektablen und hart erkämpften fünften Platz durchaus zufrieden sein.
Vielen Dank auch an die begleitenden Eltern, ohne die die An- und Abreise zum Turnier erst möglich wurde!
R. Weißenfels und C. Kauferstein
Allons en France! Romain Rolland-Programm - Individualaustausch mit Burgund im Herbst 2023
Liebe Schülerinnen und Schüler, liebe Eltern,
im Rahmen der Regionalpartnerschaft Rheinland-Pfalz – Burgund (Frankreich) bietet das Ministerium für Bildung im kommenden Schuljahr wieder ein individuelles zweiwöchiges Austauschprogramm für Schülerinnen und Schüler der Klassenstufen 8 und 9 an. Die Begegnungen finden vom 30.09. bis zum 14.10.2023 in Burgund und vom 18.11. bis zum 02.12.2023 in Rheinland-Pfalz statt.
Allons en France! Romain Rolland-Programm - Individualaustausch mit Burgund im Herbst 2023

Liebe Schülerinnen und Schüler, liebe Eltern,
im Rahmen der Regionalpartnerschaft Rheinland-Pfalz – Burgund (Frankreich) bietet das Ministerium für Bildung im kommenden Schuljahr wieder ein individuelles zweiwöchiges Austauschprogramm für Schülerinnen und Schüler der Klassenstufen 8 und 9 an. Die Begegnungen finden vom 30.09. bis zum 14.10.2023 in Burgund und vom 18.11. bis zum 02.12.2023 in Rheinland-Pfalz statt.
Die Unterbringung erfolgt in den Familien der Partnerschülerinnen und -schüler. Bewerbungen sind bis zum 17.3.2023 möglich.
Bei Fragen zum Bewerbungsverfahren und zum Austausch wendet euch bitte an Frau Eßer oder eure Französischlehrkraft.
Für alle Interessierten gibt es in der Woche ab dem 06.02. ein Infotreffen, bei dem wir auch das Bewerbungsformular besprechen werden.
Informationen zum Programm und Bewerbungsunterlagen findet ihr hier: https://eu-int.bildung-rp.de/informationen-fuer-schuelerinnen-und-schueler.html
Wir freuen uns über zahlreiche Bewerbungen!
On y va!
Antje Eßer, 26.01.2023
La journée franco-allemande 2023 – Traité de l’Élysée 60 ans
France et Allemagne – Unies pour la paix
Ein ganz besonderer Tag wird am 22. Januar 2023 gefeiert: Mit vielen Projekten und Begegnungen wird dem 22. Januar vor 60 Jahren gedacht, an dem Charles De Gaulle und Konrad Adenauer in einem besonderen Vertrag die deutsch-französische Freundschaft besiegelten. Seitdem sind etliche Städtepartnerschaften entstanden, tausende Menschen diesseits und jenseits des Rheins haben sich dadurch kennenlernen dürfen, Austausche von Schulen, Vereinen dazu beigetragen, dass sich Menschen begegnen und Vorurteile abgebaut werden.
La journée franco-allemande 2023 – Traité de l’Élysée 60 ans
France et Allemagne – Unies pour la paix

Ein ganz besonderer Tag wird am 22. Januar 2023 gefeiert: Mit vielen Projekten und Begegnungen wird dem 22. Januar vor 60 Jahren gedacht, an dem Charles De Gaulle und Konrad Adenauer in einem besonderen Vertrag die deutsch-französische Freundschaft besiegelten. Seitdem sind etliche Städtepartnerschaften entstanden, tausende Menschen diesseits und jenseits des Rheins haben sich dadurch kennenlernen dürfen, Austausche von Schulen, Vereinen dazu beigetragen, dass sich Menschen begegnen und Vorurteile abgebaut werden. Die jahrhundertealte „Erbfeindschaft“ zwischen unseren Ländern wurde besiegt, ohne Hindernisse können wir die Schönheit unserer beiden Länder kennenlernen und die Menschen, die dort wohnen, lieben lernen. Und immer wieder wird von Politikern betont, dass die Seele der deutsch-französischen Freundschaft in den Begegnungen im Kleinen und Privaten zu finden ist.
Dazu ist das Lernen der Sprache des jeweils anderen ein wichtiger Baustein. Im Französischunterricht aller Jahrgangsstufen haben wir gefragt, was für unsere SchülerInnen die Beziehung zu Frankreich ausmacht. Viele von ihnen waren bereits in Frankreich in Urlaub oder mit dem Schüleraustausch in Pornic. Sie haben neue Freunde gefunden und das Leben und die Gewohnheiten in unserem Nachbarland kennengelernt. Die jungen Menschen wünschen sich gemeinsam feiern zu können, zu essen und zu lachen, vielleicht auch im Nachbarland zu studieren oder später einmal zu arbeiten. Die Kinder aus den Klassen 6b und 6c haben sich zum Beispiel überlegt, warum sie eigentlich gerne Französisch lernen möchten und unter anderem folgende Antworten gefunden: „Französisch ist eine schöne Sprache“, „Ich möchte da mal hinfahren und mich auch unterhalten können“, „Wenn man viele Sprachen kann, ist es leichter, noch mehr Sprachen zu lernen“.
Man findet die „Seele der Freundschaft“ auch bei den 35 MGL-Schülerinnen und Schülern, die in diesem Jahr wieder am Schüleraustausch mit Pornic teilnehmen und einen großen Wunsch für eine friedliche Zukunft formulieren:
„Die Freundschaft ist wichtig, weil Freunde keinen Grund haben, sich gegenseitig zu verletzen.“ Unsere „großen“ SchülerInnen nehmen dieses Jahr an dem deutschlandweit ausgeschriebenen Internet-Teamwettbewerb teil und lösen Fragen zu Frankreich, Europa und der Frankophonie. Hier gilt es 80 Fragen aus 8 verschiedenen Themenbereichen richtig zu beantworten. Das war schon ganz schön kniffelig, so die Schüler der 13F1, die viel Spaß bei der Beantwortung hatten.
Frau Esser gilt ein herzliches Dankeschön, dass sie die Tradition dieses besonderen Tags am MGL hochhält, in dieser bewegten Zeit ein wichtiger Beitrag zur Friedensarbeit.
Claudia Herzog, 20.01.2023
Zeitungsseite_60_Jahre_Elysee.pdf
![]() |
![]() |
First Lego League Challenge 2022/23
Seit einigen Jahren gibt es am Martinus-Gymnasium für die Jahrgangsstufen 9 und 10 das Wahlfach MINT (Mathematik, Informatik, Naturwissenschaft, Technik). Aus dem Unterricht der Jahrgangsstufe 10 entwickelte sich eine Gruppe von Schülerinnen und Schülern, die sich mit Vorliebe der Robotik widmet und sich mit anderen messen wollte. Am 7. Januar 2023 war es dann soweit: Zum eraten Mal nahmen Schüler des MGL an der First Lego League (FLL) Challenge 2022/23 Roboterdesign beim Regionalwettbewerb in Vallendar teil.
First Lego League Challenge 2022/23

Regionalwettbewerb Vallendar Deutschland
Seit einigen Jahren gibt es am Martinus-Gymnasium für die Jahrgangsstufen 9 und 10 das Wahlfach MINT (Mathematik, Informatik, Naturwissenschaft, Technik). Aus dem Unterricht der Jahrgangsstufe 10 entwickelte sich eine Gruppe von Schülerinnen und Schülern, die sich mit Vorliebe der Robotik widmet und sich mit anderen messen wollte. Am 7. Januar 2023 war es dann soweit: Die Gruppen „Glurak-Liebhaber“ (5 Teilnehmer) und „Die 6 von der Tanke“ (6 Teilnehmer) nahmen zum ersten Mal an der First Lego League (FLL) Challenge 2022/23 Roboterdesign beim Regionalwettbewerb in Vallendar teil.
Ihr Thema war Energieeffizienz, dazu bekamen sie einen Forschungsauftrag, den sie im Team bearbeiten mussten. Robot-Game und Robot-Design gehörten mit zur Challenge. Insgesamt gab es 24 Aufgaben, die in 2 Minuten 30 Sekunden zu bewältigen waren. In den Ferien und an mehreren Intensivtagen hatten sich die jungen Forscher zum Proben und Tüfteln getroffen. Der Lohn der Arbeit: Ein für das erste Mal guter 5. und 6. Platz und ein Sonderpreis für Roboterdesign! Auf die Frage, was man zur Lösung von Robotik Challenges am meisten braucht, antworteten Jonas Antweiler und Jan Richarz unisono: Spaß am Programmieren, Problemorientierung und unendliche Geduld.
Herzlichen Glückwunsch an unsere beiden Teams und vielen Dank an ihren betreuenden Lehrer, Herrn Weißenfels!
Claudia Herzog, 16.01.2023
„EinBlick in die Chemie“ an der Uni Bonn
Am Mittwochnachmittag (11.01.23) schnupperte der Chemie-LK MSS12 Hörsaal-Luft: Am chemischen Institut der Uni Bonn verfolgten wir den Vortrag von Prof. Höger zum Thema Polymere: Strukturen und Eigenschaften omnipräsenter Materialien.
„EinBlick in die Chemie“ an der Uni Bonn

Am Mittwochnachmittag (11.01.23) schnupperte der Chemie-LK MSS12 Hörsaal-Luft: Am chemischen Institut der Uni Bonn verfolgten wir den Vortrag von Prof. Höger zum Thema Polymere: Strukturen und Eigenschaften omnipräsenter Materialien. Polymere sind aus unserem Alltag nicht wegzudenken, Kunststoffe sind heutzutage überall im Einsatz. Die Einsatzmöglichkeiten sind aber bei weitem noch nicht ausgeschöpft, sondern gleichzeitig immer noch Gegenstand hochaktueller Forschung, wie Prof. Höger aufzeigte.
Im Anschluss an den Vortrag durften wir im Rahmen einer Laborführung noch den Ort besuchen, an dem die Forschung betrieben wird. Die zahlreichen Geräte, Aufbauten, Poster und auch ein Experiment mit flüssigem Stickstoff beeindruckten.
Informationen der Fachschaft Chemie zum Studium an der Uni Bonn rundeten unseren Besuch am chemischen Institut ab.
16.01.2023, L. Tironi
Rückblick auf das Weihnachtskonzert des MGL
Große und kleine Musiker, Solisten und Ensembles, Chöre, die Bläserklassen der Jahrgangsstufe 5 und 6, die Concert Band und die Big Band verzauberten am Weihnachtsfest die Schulgemeinschaft des MGL.
Rückblick auf das Weihnachtskonzert des MGL

Große und kleine Musiker, Solisten und Ensembles, Chöre, die Bläserklassen der Jahrgangsstufe 5 und 6, die Concert Band und die Big Band verzauberten am Weihnachtsfest die Schulgemeinschaft des MGL. Mit einem großartigen Aufgebot von 95 Schülerinnen und Schülern erlebten die Zuschauer in der restlos ausverkauften Stadthalle einen wunderbaren Vorweihnachtsabend. Unsere jungen Künstlerinnen und Künstler gaben ihr Bestes und wurden mit rauschendem Applaus belohnt. Wie schön, dass die Video-AG die Höhepunkte des Abends für uns festgehalten hat.
Wir danken allen, die diesen wunderbaren Abend mitgestaltet haben. Ein herzlicher Dank geht an unsere beiden Musiklehrer Frau Schnabel und Herrn Lehmann, die mit viel Engagement und Geduld die Schülerinnen und Schüler begleitet haben.
C. Herzog, 02.01.2023
![]() |
![]() |
![]() |
![]() |
![]() |
![]() |
![]() |
![]() |
![]() |
Erstes Weihnachts-Volleyballturnier am MGL ein voller Erfolg!
Am Donnerstag, 15.12.2022, war es soweit! Die beiden Turnhallen waren gefüllt mit motivierten Sportlern, welche entweder beim Spiel „Ball über die Schnur“ oder Volleyball den jeweiligen Jahrgangsstufen – Sieger ermittelten.
Erstes Weihnachts-Volleyballturnier am MGL ein voller Erfolg!

Am Donnerstag, 15.12.2022, war es soweit! Die beiden Turnhallen waren gefüllt mit motivierten Sportlern, welche entweder beim Spiel „Ball über die Schnur“ oder Volleyball den jeweiligen Jahrgangsstufen – Sieger ermittelten.
Alle hatten großen Spaß, denn nach Langem waren wieder die verschiedenen Klassenstufen zusammen und konnten sich miteinander messen und gemeinsam Spass haben.
Für die gute Vorbereitung und Organisation des Turniers bedanken wir uns beim VfB Linz, Herrn Erlenbach (Leiter der Volleyball- AG) und Frau Schuh, sowie den zahlreichen Schüler-Schiris.
S. Meurer
![]() |
![]() |
MGL - Schüler schreiben für die Freiheit: Briefmarathon von Amnesty international
Anlässlich des Internationalen Tags der Menschenrechte am 10. Dezember 2022 startet Amnesty International, erneut einen Briefmarathon. Schulen und Jugendverbände sind vom 15. November bis zum 22. Dezember 2022 aufgerufen, sich für Menschen einzusetzen, deren Rechte fundamental missachtet werden.
MGL - Schüler schreiben für die Freiheit: Briefmarathon von Amnesty international

Anlässlich des Internationalen Tags der Menschenrechte am 10. Dezember 2022 startet Amnesty International, erneut einen Briefmarathon. Schulen und Jugendverbände sind vom 15. November bis zum 22. Dezember 2022 aufgerufen, sich für Menschen einzusetzen, deren Rechte fundamental missachtet werden.
In einem Briefmarathon sollen die Teilnehmenden ihre Solidarität mit gewaltlosen politischen Gefangenen ausdrücken oder Regierungen auffordern, Menschenrechtsverteidigerinnen und -verteidiger freizulassen.
„Schreib für die Freiheit“ war dann auch das Motto für die Schülerinnen und Schüler aus den beiden katholischen Religionskursen der Jahrgangsstufe 10, in ganz persönlichen Briefen setzen sie sich aktiv für Menschenrechte eingesetzt. In diesen fordern sie die Freilassung von politischen Gefangenen, die gewaltlos ihren Protest ausdrückten und dafür verurteilt wurden, wie z. B. für Chow Hang-Tung, eine Aktivistin, die in Hongkong wegen einer Kerzenandacht zu 10 Jahren Gefängnis verurteilt wurde, oder Vahid Afkari, ein Iraner, der seit 2018 in Einzelhaft sitzt, weil er an Protesten gegen Ungleichheit und politische Unterdrückung teilgenommen hat.
Weitere Informationen gibt es hier: https://www.bildungsserver.de/nachricht.html?nachricht_id=240
S. Meurer, C. Herzog, 9.12.2022
Wie läuft’s im Rathaus?
Theorie muss sein, richtig spannend wird es aber, wenn das Gelernte an der Realität gemessen wird. Deshalb besuchte die 9a am 24. November das Rathaus in Linz und wurde dort vom Bürgermeister Herrn Dr. Faust im Historischen Rathaussaal empfangen.
Wie läuft’s im Rathaus?

Theorie muss sein, richtig spannend wird es aber, wenn das Gelernte an der Realität gemessen wird. Deshalb besuchte die 9a am 24. November das Rathaus in Linz und wurde dort von Bürgermeister Herrn Dr. Faust im Historischen Rathaussaal empfangen. Ausführlich erläuterte er seine Aufgaben, seine Hoffnungen und Pläne für Linz, die Besonderheiten unserer Stadt, die Zusammenarbeit mit dem Land, das neue Projekt Smart City, die Vorteile des Kooperationsvertrages mit unserem Gymnasium und vieles mehr. Eine Stunde lang stellten die Schülerinnen und Schüler Fragen und verglichen die Theorie aus dem Schulbuch mit der Praxis der Kommunalpolitik eines erfahrenen Politikers. Fazit: Nichts geht über den persönlichen Austausch und erst so wird Politik interessant und mit Leben gefüllt. Tatsächlich könnten sich einige der Schülerinnen und Schüler jetzt, nach ihrem Besuch, vorstellen, in Zukunft in der Jugendvertretung oder in anderen Gremien mitzuarbeiten. Auch hier machte Dr. Faust ihnen Mut: „Kommt mit konkreten Wünschen und Vorschlägen zu uns, wir können ganz viel möglich machen!“ H. Nefigmann, 9.12.2022
Das MGL nutzt die Kraft der Sonne - Einweihung der Photovoltaik-Anlage am Martinus-Gymnasium
Hoher Besuch am MGL: Landrat Achim Hallerbach und 1. Kreisbeigeordneter Michael Mahlert weihten in einer kleinen Feierstunde auf dem Schulhof die neue PV-Anlage auf dem Dach des Nebengebäudes mit insgesamt 86 Modulen ein.
Das MGL nutzt die Kraft der Sonne - Einweihung der Photovoltaik-Anlage am Martinus-Gymnasium

Hoher Besuch am MGL: Landrat Achim Hallerbach und 1. Kreisbeigeordneter Michael Mahlert weihten in einer kleinen Feierstunde auf dem Schulhof die neue PV-Anlage auf dem Dach des Nebengebäudes mit insgesamt 86 Modulen ein. Es wird erwartet, dass die 29,6 kWp große Anlage zu einer CO2-Ersparnis von 8.539 kg pro Jahr führen wird. „Damit ist das MGL ein Leuchtturmprojekt in unserem Kreis, wir hoffen, noch weitere Schulen mit PV ausstatten zu können“, so Hallerbach.
Rückblick: Begonnen hatte alles vor drei Jahren, als sich Schülerinnen und Schüler der Nachhaltigkeits-AG u.a. Gedanken über alternative Energiequellen für das MGL machten und in Kontakt mit dem Kreis getreten sind. Neben vielen anderen gelungenen Projekten unserer aktiven Schülerschaft, ist der Bau der PV-Anlage der größte Erfolg der Nachhaltigkeits-AG. Und eins ist klar: Nur gemeinsam, mit Schülerinnen und Schülern, Schulleitung und den Verantwortlichen beim Kreis Neuwied können wir diese und weitere Projekte für uns und die kommenden Generationen schultern. In unserem Nachhaltigkeitsausschuss sind demnach auch Mitglieder aller Gremien vertreten.
Unser Dank gilt allen Beteiligten für ihre konstruktiven Ideen, ihre Hilfe und Arbeit zugunsten einer nachhaltigen Zukunft, wir hoffen auf möglichst viele „Nachahmer“!
C. Herzog, 29.11.2022
Internationaler Tag gegen Gewalt an Frauen – 25.11.2022
Ein internationales Treffen fand an diesem Tag am MGL statt, wenn auch nur digital. Um dem Thema Gewalt gegen Frauen mehr Aufmerksamkeit zu widmen, schlossen sich Schülerinnen und Schüler aus drei Nationen zu einer gemeinsamen Aktion zusammen.
Internationaler Tag gegen Gewalt an Frauen – 25.11.2022

Ein internationales Treffen fand an diesem Tag am MGL statt, wenn auch nur digital. Um dem Thema Gewalt gegen Frauen mehr Aufmerksamkeit zu widmen, schlossen sich Schülerinnen und Schüler aus drei Nationen zu einer gemeinsamen Aktion zusammen: Pornic, Frankreich, unter der Leitung von Marie-Agnès Morice, Baione, Spanien und Linz am Rhein, unter der Leitung von Antje Eßer.
Die Schülerinnen und Schüler trugen Texte von Künstlerinnen, Politikern und Aktivistinnen vor, die sich mit dem brisanten Thema „Gewalt an Frauen“ befassen. Dabei geht es um häusliche Gewalt, die nach außen oft wenig sichtbar ist und sexualisierte Gewalt, die im öffentlichen Raum stattfindet. Es geht darum, das Thema zu enttabuisieren, die Öffentlichkeit wachzurütteln. Als Zeichen der Verbundenheit und der internationalen Aktualität ließen alle Schülerinnen und Schüler zur gleichen Zeit ihr Handy in der Farbe „lila“ aufleuchten. Hinschauen und aktiv werden, wenn etwas passiert, da sind sich Franzosen, Spanier und Deutsche einig!
C. Herzog, 29.11.2022
![]() |
![]() |
Mathematik auf universitärem Niveau - Beachtliche Leistung unserer Schüler am Hausdorff Center for Mathematics, Bonn
Der Laudator, Herr Hartmann, sparte nicht an Lob, als er den Schülern der Mathematik Leistungskurse der MSS 12 und 13 die wohlverdienten Urkunden überreichte. Er betonte, dass die Schüler auch deshalb so gut abgeschlossen haben, weil sie als Team perfekt zusammengearbeitet haben. „Mathematik ist keine einsame Wissenschaft, sie ist vor allem internationale Teamarbeit“, so Hartmann.
Mathematik auf universitärem Niveau - Beachtliche Leistung unserer Schüler am Hausdorff Center for Mathematics, Bonn

Der Organisator des Wettbewerbs besucht das Martinus-Gymnasium und überreicht den wohlverdienten Preis
Der Laudator, Herr Hartmann, sparte nicht an Lob, als er den Schülern der Mathematik Leistungskurse der MSS 12 und 13 die wohlverdienten Urkunden überreichte. Er betonte, dass die Schüler auch deshalb so gut abgeschlossen haben, weil sie als Team perfekt zusammengearbeitet haben. „Mathematik ist keine einsame Wissenschaft, sie ist vor allem internationale Teamarbeit“, so Hartmann.
Bericht vom eigentlichen Turnier
Am Morgen des 23. Septembers traf sich unser Team des MGLs – bestehend aus Max Kurtenbach, Simon Waldek, Marcel Weißenfels (alle MSS12), Sebastian Bensch und Hannah Lindner (beide MSS13) – in Begleitung von Frau Tironi, um sich auf den Weg zum Bonner Mathematikturnier zu machen. Gegen 10:30 Uhr kamen wir an der Campusmensa in der Nähe des Hausdorff Center for Mathematics an. In der Mensa reihten sich bereits die vielen Tische für die einzelnen Schulen aneinander und viele der insgesamt 69 Schulteams waren bereits eingetroffen. Nach kurzer Zeit begann das Turnier mit der ersten Runde, der Staffel. Dort galt es, als Team in 60 Minuten von 20 Aufgaben so viele wie möglich zu lösen. Für die Aufgaben hatten wir je nach Schwierigkeitsgrad bis zu drei Lösungsversuche. Abhängig von dem Schwierigkeitsgrad bekam das Team für eine richtige Lösung 20 oder 30 Punkte, die auf einer Tabelle notiert wurden, sodass der Zwischenstand im Verlauf der Runde immer zu sehen war. Hier stellten sich auch zwei Dreamteams dem Wettbewerb – ein Team bestehend aus Mathelehrer/innen und eines aus Matheprofessor/innen!
Am Ende der ersten Runde schafften wir von 500 möglichen 140 Punkte, womit wir im oberen Mittelfeld landeten. So ging es dann mit diesem angesichts der Konkurrenz zufriedenstellenden Zwischenergebnis in die Mittagspause.
Nach einer Stärkung in der Mensa ging es dann mit der zweiten Runde „Sum of us“ weiter. Hierfür hatten wir uns im Vorfeld mit umfangreichem Übungs- und Vorbereitungsmaterial und guter Unterstützung von Herrn Waldek ein völlig neues Thema erarbeitet: die Max-Plus-Algebra. Die Max-Plus-Algebra ist eine neue Algebra, also ein Rechensystem, mit der zum Beispiel Fahrpläne erstellt und optimiert werden können. Für diese Runde bekamen wir einen Bogen mit Aufgaben, welche wir innerhalb von 1,5 Stunde in der Gruppe bearbeiten sollten. Als dann auch diese Runde vorbei war und die Aufgabenbögen in der Auswertung waren, gab es einen Vortrag zur tropischen Geometrie, der Geometrie der Max-Plus-Algebra. Nach diesem spannenden Vortag sollte es eigentlich die Siegesehrung geben, welche leider abgesagt werden musste, da die Ergebnisse noch nicht vollständig ausgezählt worden waren. So erfuhren wir erst am späten Abend, dass wir bei der zweiten Runde von 500 möglichen unglaubliche 496 Punkte erreichten und uns so auf Platz 5 von 69 der Gesamtwertung gekämpft haben.
S. Bensch, MSS13
![]() |
![]() |
Seasons of Love - das Musical 2022 am MGL
Am 03.11.2022 hatten wir, die Musical-AG und die BigBand des Martinus-Gymnasiums Linz, unsere Premiere in der Stadthalle, denn wir führten unter der Regie und Leitung von Herrn Tobias Lehmann unser selbstgeschriebenes Musical „Seasons of Love" auf.
Seasons of Love
Am 03.11.2022 hatten wir, die Musical-AG und die BigBand des Martinus-Gymnasiums Linz, unsere Premiere in der Stadthalle, denn wir führten unter der Regie und Leitung von Herrn Tobias Lehmann unser selbstgeschriebenes Musical „Seasons of Love" auf.
Unser Stück handelt von einer Liebesgeschichte. Die beiden Hauptrollen, die von Kim Bösche und Florian Velling gespielt werden, verkörpern ein Liebespaar, doch ihre Liebe wird durch eine Sekretärin (Elena Riebartsch) und einer Wahrsagerin (Jule Becker) auf die Probe gestellt, aber diese Hürden können sie mit Hilfe ihrer Freunde, die von Carolina Cornvinus, Alexander Böyer und Sophie Dick gespielt werden, überwinden. Schon um 19:00 Uhr war die Stadthalle gefüllt mit interessiertem Publikum. Wir waren voller Vorfreude und Aufregung, als sich der Vorhang öffnete und wir in die in die begeisterten Gesichter der Menschen blickten. Unser Stück besteht aus Schauspiel, Gesang, Tanz und Soloeinlagen der Musiker – alles live gespielt und gesungen. Unser tolles Publikum nahm das mit Begeisterung auf. Vor allem gab es Begeisterungsstürme, als u.a. unsere Linzer BackStreetBoys auf die Bühne traten.
Nicht nur am Ende unseres Auftritts gab es viel Applaus und strahlende Gesichter, sondern auch während des Musicals gab es Zwischenapplaus für jede einzelne Darbietung.
Insgesamt war es ein unvergesslicher Abend für alle Beteiligten.
N. Riemann, November 2022
Fotos von der Aufführung...
![]() |
![]() |
![]() |
![]() |
![]() |
![]() |
![]() |
![]() |
![]() |
![]() |
![]() |
![]() |
![]() |
![]() |
![]() |
![]() |
![]() |
![]() |
Martinus konkret
Martinus-Gymnasium Linz sammelt für die Linzer Tafel
Seit mehr als zehn Jahren wird rund um den Gedenktag des Sankt Martins eine großangelegte Spendenaktion in der Schulgemeinschaft des MGL durchgeführt. Die Dringlichkeit in diesem Jahr, neben den Gaben der Lebensmittelgeschäfte möglichst viele Spenden zu erhalten, erklärt Dr. Werner Dötsch, Vorsitzender der Linzer Tafel, vor allem mit dem Zuzug der vielen geflüchteten ukrainischen Menschen, die in Linz eine Bleibe gefunden haben.
Martinus konkret

Martinus-Gymnasium Linz sammelt für die Linzer Tafel
Seit mehr als zehn Jahren wird rund um den Gedenktag des Sankt Martins eine großangelegte Spendenaktion in der Schulgemeinschaft des MGL durchgeführt. Die Dringlichkeit in diesem Jahr, neben den Gaben der Lebensmittelgeschäfte möglichst viele Spenden zu erhalten, erklärt Dr. Werner Dötsch, Vorsitzender der Linzer Tafel, vor allem mit dem Zuzug der vielen geflüchteten ukrainischen Menschen, die in Linz eine Bleibe gefunden haben. Im Fach Religion der Jahrgangsstufe 9 wurde über die wichtige, ehrenamtliche Arbeit der Linzer Tafel informiert. Die Schülerinnen und Schüler wollten sich dann sogleich selbst engagieren und riefen in den einzelnen Klassen zu Spenden für die Tafel auf. Zusätzlich zur Aktion in der Schule sammelten sie zweimal am Freitagnachmittag und an zwei Samstagen vor Edeka Fett. Der Lebensmittelladen unterstützt uns dankenswerterweise jedes Jahr, indem er die gespendeten Waren im Kühlraum lagert, bis sie von Mitarbeitern der Tafel abgeholt werden.
Insgesamt kamen in diesem Jahr 17 hochvolle Einkaufswagen und Geldspenden in Höhe von € 1.215, 58 zusammen, die Gelder werden für die gestiegenen Sprit- und Energiekosten dringend gebraucht. Die Schülerinnen und Schüler konnten am Dienstag, 15.11.2022, die Waren und das Geld an Dr. Werner Dötsch und Bernd Weber von der Linzer Tafel übergeben. Herzlichen Dank an die Schulgemeinschaft, aber natürlich auch an alle Bürgerinnen und Bürger der Stadt Linz, die unsere Aktion so großzügig unterstützt haben.
Alle gemeinsam, Spender und natürlich ehrenamtliche Mitarbeiter der Tafel, können wir die Not vieler lindern!
C. Herzog, 15.11.2022
![]() |
![]() |

Übergabe Zertifikate Courage-Scout
20 Schülerinnen und Schüler des MGL konnten heute ihre Zertifikate nach abgeschlossener Ausbildung zum Courage-Scout in Empfang nehmen. Sie hatten in einem 3-tägigen Seminar Formen von Diskriminierung und Rassismus kennengelernt und können nun jüngere Mitschüler für diese Thematik sensibilisieren. Diese Form von Prävention ist Teil von Demokratiebildung, die dem bundesweiten Netzwerk unter dem Namen SOR-SMC (Schule ohne Rassismus - Schule mit Courage) angeschlossen ist und an unserer Schule seit Jahren praktiziert wird.
C. Herzog, 11.11.2022
Das MGL geht einen Schritt weiter auf dem Weg nach Europa
Nach dem theoretischen Schritt der Akkreditierung des MGL zur ERASMUS+-Schule folgte ein konkreter Schritt: Dieser führte fünf Lehrkräfte in der zweiten Woche der Herbstferien nach Thessaloniki
Das MGL geht einen Schritt weiter auf dem Weg nach Europa

Nach dem theoretischen Schritt der Akkreditierung des MGL zur ERASMUS+-Schule folgte ein konkreter Schritt: Dieser führte fünf Lehrkräfte in der zweiten Woche der Herbstferien nach Thessaloniki. Die (erweiterte) Schulleitung, vertreten durch Thomas Schmacke, Ralf Weißenfels und Sonja Kosch, sowie die Kolleginnen Antje Eßer und Heike Nefigmann nahmen an einem Seminar der Europa-Kontakt-Akademie in Griechenland teil. Ein Ziel des Aufenthaltes war, die neue Akkreditierung als Erasmus+ Schule zu nutzen, um Kontakte mit griechischen Schulen zu knüpfen. Deshalb war ein Teil der Woche dafür vorgesehen, mit griechischen Kolleginnen und Kollegen in Interaktion zu kommen und sich näher kennenzulernen, ob eine Zusammenarbeit und Begegnung möglich sein könnte. Es wurden viele Ideen und später auch Email-Adressen ausgetauscht. Das zweite Ziel war die ganz konkrete Vorbereitung von Projektarbeit. Das MGL ist bestrebt, analog und/oder digital Unterrichtsvorhaben mit griechischen und anderen Schulen im europäischen Raum zu planen, durchzuführen und zu evaluieren.
Eine arbeitsame und intensive Woche, gespickt mit Kontakten zu griechischen Lehrerinnen, viel Theorie, vielen Challenges und viel Lachen mit gleichgesinnten Kolleginnen und Kollegenliegen hinter der MGL-Delegation. Nun gilt es, die neuen Ideen in konkrete Unterrichtsvorhaben zu verwandeln und mit Schülerinnen und Schülern des MGL in Linz und anderswo mit Leben zu füllen und durchzuführen. Seid gespannt!
H. Nefigmann, C. Herzog, 07.11.2022
t
Die Klassen 10b und 10c auf Geschichts-Exkursion zur Gedenkstätte Hadamar bei Limburg
Im Rahmen des Faches Geschichte unternahmen die Klassen 10b (Herr Walker) und 10c (Frau Meurer) vor den Herbstferien eine Gedenkstätten-Fahrt. Wir besuchten die ehemalige NS- Tötungsanstalt Hadamar bei Limburg, wo zur Zeit des Zweiten Weltkrieges um die 15.000 Menschen ums Leben gebracht wurden. Die Tötungen fanden statt im Zusammenhang mit dem NS- „Euthanasie“-Programm.
Die Klassen 10b und 10c auf Geschichts-Exkursion zur Gedenkstätte Hadamar bei Limburg

Im Rahmen des Faches Geschichte unternahmen die Klassen 10b (Herr Walker) und 10c (Frau Meurer) vor den Herbstferien eine Gedenkstätten-Fahrt. Wir besuchten die ehemalige NS- Tötungsanstalt Hadamar bei Limburg, wo zur Zeit des Zweiten Weltkrieges um die 15.000 Menschen ums Leben gebracht wurden. Die Tötungen fanden statt im Zusammenhang mit dem NS- „Euthanasie“-Programm.
In der ersten Phase von Januar bis August 1941 sind an diesem Ort über 10.000 psychisch kranke und geistig behinderte Menschen in einer Gaskammer mit Kohlenmonoxyd vergiftet worden. Nach dem Protest des damaligen Bischofs von Münster, Kardinal von Galen, der in mehreren Predigten 1941 dieses Verbrechen der Nationalsozialisten mutig kritisierte, wurden die Tötungen seitens des Regimes kurzfristig eingestellt. Ab 1942 gingen die Morde am selben Ort mit anderen Mitteln weiter. In Hadamar wurden dann Kranke und Behinderte mit einer Überdosis von Schlaf- und Beruhigungsmitteln vergiftet. Dieser zweiten Phase fielen noch einmal fast 5000 Menschen zum Opfer.
Vor Ort erhielten die Schülerinnen und Schüler vertiefende Informationen durch zwei Gedenkstätten- mitarbeiterinnen. Anschließend gingen wir den Weg ab, den früher die Opfer von der Busgarage über die Gänge im Klinikgebäude bis zur Gaskammer im Keller gelaufen sind. Von den einstigen Krematoriumsöfen sind Fundamentreste und einzelne technische Vorrichtungen noch heute erkennbar. Ebenso befindet sich an Ort und Stelle ein Seziertisch: Nach der Ermordung in der als Duschraum getarnten Gaskammer wurden manchen Leichen die Gehirne zu „Forschungszwecken“ entnommen. Auch Goldzähne wurden den Opfern herausgebrochen.
Nach dem Zweiten Weltkrieg gerieten die Räumlichkeiten lange in Vergessenheit und sie wurden als Abstellkammer benutzt. Erst in den 1980er Jahren begann die wissenschaftliche Aufarbeitung. Deren Ergebnis ist u. a. die Dauerausstellung mit dem Titel „Verlegt nach Hadamar“, die zu festen Öffnungszeiten auch privat besucht werden kann.
Wir danken den Mitarbeiterinnen und Mitarbeitern der Gedenkstätte für die sehr gute pädagogische Betreuung. Dank der Führung wurde allen Teilnehmern das Ausmaß der nationalsozialistischen Verbrechen unmittelbar bewusst gemacht.
S. Walker
Polenaustausch am MGL
Vom 04.10.2022 bis 11.10.2022 kamen 13 Schüler/innen des Don Bosco Lyzeum aus Krakau zu uns ans Martinus-Gymnasium Linz.
Die anfängliche Zurückhaltung und freudige Aufregung unsererseits wich mit der Ankunft unserer Austauschpartner/innen aus Krakau sehr schnell.
Polenaustausch am MGL

Vom 04.10.2022 bis 11.10.2022 kamen 13 Schüler/innen des Don Bosco Lyzeum aus Krakau zu uns ans Martinus-Gymnasium Linz. Die anfängliche Zurückhaltung und freudige Aufregung unsererseits wich mit der Ankunft unserer Austauschpartner/innen aus Krakau sehr schnell.
Bereits am ersten Tag führten wir eine Stadtrallye durch Linz und wanderten im Anschluss auf den Drachenfels hinauf. In den darauffolgenden Tagen zeigten wir unserer Austauschpartner/innen die nähere Umgebung, indem wir u.a. Ausflüge nach Köln, Bonn und Koblenz durchführten. Neben dem sportlichen Kräftemessen und interessanten sportgeschichtlichen Fakten im Sport- und Olympia-Museum in Köln besuchten wir auch den Kölner Dom und erhielten von Herrn Meixner einige spannende Hintergrundinformationen zum Richter-Fenster. Der nächste Ausflug führte uns nach Bonn, wo eines der Höhepunkte der Haribo-Shop war, neben dem kulturellen Programm im Beethoven-Haus und im Haus der Geschichte. Am letzten gemeinsamen Tag fuhren wir gemeinsam nach Koblenz, um dort an einer Stadtführung teilzunehmen. Zwischendurch hatten wir auch genug Zeit, um selbst die Stadt mit unseren Partnern zu erkunden und uns auch näher kennenzulernen.
Nach den Schulausflügen, genauso wie auch am Wochenende, konnten wir die Zeit mit unseren Austauschpartner/innen selber gestalten, u.a. so aßen wir gemeinsam am Rhein Pizza, trafen uns auf dem Kaiserberg, spielten Fußball und Basketball und brachten uns gegenseitig Tänze bei.
Jede gemeinsame Aktivität brachte uns alle näher und es wurden schnell Freundschaften geschlossen, weshalb der Abschied für viele auch unter Tränen stattfand.
Doch schon nächstes Jahr 2023 fliegen wir mit großer Vorfreude nach Krakau zu unseren neuen polnischen Freunden. Insgesamt war der Austausch in Linz für jeden eine besondere Erfahrung sowohl für die Schüler/innen aus Krakau als auch für die Schüler/innen aus Linz. Diesen Besuch wird wahrscheinlich keiner so schnell vergessen und er bleibt ein prägendes Erlebnis für jeden von uns in seiner gesamten Schullaufbahn.
![]() |
Die Jahrgangsstufe 7 auf Klassenfahrt
Die Klassen 7 des MGL waren nach langer Corona-Pause endlich wieder auf Klassenfahrt. Mein Name ist Lennox Nietzard, gehe in die 7b und erzähle euch hier von unserem Ausflug.
Es ging vom 19.-21.09.2022 nach Rurberg in der Eifel. Wir waren alle sehr gespannt auf diese Fahrt und freuten uns, in der neu zusammengesetzten Klasse drei Tage in der Jugendherberge am Ruhrsee zu erleben.
Die Jahrgangsstufe 7 auf Klassenfahrt

Die Klassen 7 des MGL waren nach langer Corona-Pause endlich wieder auf Klassenfahrt. Mein Name ist Lennox Nietzard, gehe in die 7b und erzähle euch hier von unserem Ausflug.
Es ging vom 19.-21.09.2022 nach Rurberg in der Eifel. Wir waren alle sehr gespannt auf diese Fahrt und freuten uns, in der neu zusammengesetzten Klasse drei Tage in der Jugendherberge am Ruhrsee zu erleben.
Los ging es mit dem Bus. Die Klassen „7a“ und „7c“ hatten ihren eigenen Bus und die „7b“ wurde auf diese aufgeteilt.
Auf dem Weg am Phantasialand vorbei sahen wir einen Regenbogen. Umso näher wir kamen, desto lauter wurde es im Bus. Die Aufregung war nicht mehr zu überhören! Als wir ankamen, mussten wir ein paar Schritte laufen, bis wir endlich auf den Vorplatz der Jugendherberge standen. Es ist ein schönes großes Gebäude, das von vorne sehr klein wirkt aber von innen und von hinterm Haus riesig ist. Nach einiger Zeit im Kalten durften wir dann erstmal in unseren Aufenthalts- und Speiseraum, den wir für die Klasse hatten. Jeder Raum hatte seinen eigenen Namen.
Die Klassen „a“ und „b“ hatten einen gemeinsamen Raum, die „c“ aber hatten einen eigenen Raum daneben. Dort frühstückten wir, aßen zu Mittag und zu Abend. Erst besprachen wir die Regeln etc., dann ging es auf die Zimmer. Dort bezogen wir die Betten und dann ging es nach draußen zum Treffpunkt (auf dem Vorplatz). Dort wurden erst die Handys eingesammelt, dann machten wir die ersten Spiele mit Reifen und Wänden aus Planen. Bei diesen mussten wir uns an den Händen fassen und so durch die Reifen steigen, aber trotzdem noch im geschlossenem Kreis bleiben. Diese Übung meisterten wir mit Bravour und nach einer kleinen Pause ging es an eine Übung, bei der wir zwei Gruppen bildeten und zwischen uns eine Wand war. Die Aufgabe war es, sollte die Wand fallen, muss man so schnell wie möglich den Namen des anderen sagen und der, der Schnellste bekommt diese Person dazu in sein Team. Wer am Ende die meisten Personen hatte, hatte gewonnen. Dann war es bald schon Zeit fürs Abendessen.
Für den Abend hatten wir den Discoraum gebucht. Oben im Raum unserer Klasse war ein Projektor aufgestellt, wo dann ein Film lief, den aber nur ein Viertel von uns schaute. Die meisten feierten in der Disco und tanzten zur coolen Musik. Am Morgen gingen dann ein paar Schüler bzw. vier und Herr Dobler 7,4 Kilometer laufen mit ungefähr 170 Höhenmetern (vor dem Frühstück!).Danach gingen wir vier noch schnell duschen und dann zum Frühstück. An zwei Tagen gingen wir klettern. Am zweiten Tag ging es zu einer neu eröffneten Station, an der wir kletterten und später noch zu verschiedenen Stationen mit Betreuern, die diese erklärten. Es ging darum, eine flache, senkrechte Wand hochzukommen ohne Hilfsmittel, nur mit uns. Einige sollten dastehen und auffangen, falls jemand fiel (spotten), und der Rest half beim Hochkommen. Es gelang uns sehr gut bis auf zwei Personen, die nicht mehr hochkamen, weil der Rest, der schon oben war, nicht mehr helfen durfte. An einer anderen Station ging es darum, Holzklötze im Team aufeinander zu stapeln, was uns auch schnell im Team gelang.
Wie man auf den Bildern sieht, hat jeder einen oder zwei Fäden. Damit mussten wir dann als Team arbeiten. Dann gab es noch die Station, bei der wir uns selber als Team einen Gurt anziehen und dann uns einklinken sollten, bis wir dann von ein paar Leuten an einem Seil auf eine gewünschte Höhe hochgezogen wurden, wo wir uns dann ausklinkten und fallen ließen. Wir nannten es „7b Airlines“, denn diese Seilrutsche war wie ein Flug mit einer Rakete! Am Abend spielten wir dann Hide and Seek in und außerhalb der Jugendherberge, was einfach Spaß gemacht hat.
Am letzten Tag gingen wir dann wandern (ungefähr die Strecke, die wir am letzten Morgen auch gejoggt sind). Danach wurden wir dann mit dem Bus abgeholt. Doch auf der Rückfahrt war nur alles viel leiser, weil alle irgendwie erschöpft waren. Aber alle fanden es cool und es hat einen riesigen Spaß gemacht.
Das war unsere Klassenfahrt 2022 und es folgen hoffentlich noch viel mehr!!!
L. Nietzard (7b), 11.11.2022
![]() |
![]() |
![]() |
Schüler helfen Schülern - Medienscouts im Einsatz!
Wer sind die Medienscouts und was machen sie?
Unsere diesjährig ausgebildeten Medienscouts haben vor den Herbstferien in kurzen Workshops Schülern aus der Jahrgangsstufe 5 die neue Schul-App WebUntis nähergebracht. Sie erklärten ihnen die einzelnen Funktionen von WebUntis, zeigten ihnen, wie man Nachrichten liest und verschickt und halfen bei Log-in-Problemen.
Schüler helfen Schülern - Medienscouts im Einsatz!

Wer sind die Medienscouts und was machen sie?
Bei den Medienscouts handelt es sich um Schüler aus den Jahrgangsstufen 8-10. Sie haben im vergangenen Jahr eine online-Ausbildung absolviert, welche sie dazu berechtigt, ihre Mitschüler über Themen wie u.a. Cyberkriminalität, Chancen und Risiken von Online-Games und Sicherheit im Netz zu informieren. In einer wöchentlich stattfindenden AG haben sie ihr bereits erworbenes Wissen vertieft umdann in Eigenregie vor den Sommerferien die Projekttage „Hate Speech“ zu planen und durchzuführen.
"Medienscouts.rlp" ist eingebunden in das Projekt "Schulen in Rheinland-Pfalz sicher im Netz", dessen Ziel es ist, Themen des Jugendmedienschutzes durch ein zielgruppenspezifisches Maßnahmenpaket (Information, Kommunikation, Partizipation) für Schülerinnen und Schüler, Lehrkräfte und Eltern im Schulalltag zu verankern. Nähere Informationen sind auf der Homepage des Pädagogischen Landesinstituts Rheinland-Pfalz unter www.medienscouts.rlp.de abrufbar.
Unsere diesjährig ausgebildeten Medienscouts haben vor den Herbstferien in kurzen Workshops Schülern aus der Jahrgangsstufe 5 die neue Schul-App WebUntis nähergebracht. Sie erklärten ihnen die einzelnen Funktionen von WebUntis, zeigten ihnen, wie man Nachrichten liest und verschickt und halfen bei Log-in-Problemen.
Falls du jetzt auch Interesse an der Arbeit der Medienscouts hast und gerne Teammitglied werden willst, dann melde dich bei uns:
Geldner@martinus-gymnasium.de
Meurer@martinus-gymnasium.de
St. Meurer, 28.10.2022
Schüleraustausch Pornic – Linz im 35. Jubiläumsjahr der Städtepartnerschaft
Das lange Warten hatte ein Ende! Nach zwei Jahren Zwangspause konnte endlich wieder unser traditionsreicher Schüleraustausch mit dem Collège Jean Mounès aus Pornic stattfinden.
Schüleraustausch Pornic – Linz im 35. Jubiläumsjahr der Städtepartnerschaft

Das lange Warten hatte ein Ende! Nach zwei Jahren Zwangspause konnte endlich wieder unser traditionsreicher Schüleraustausch mit dem Collège Jean Mounès aus Pornic stattfinden.
Als unsere Gäste aus Pornic am 29. September nach 15 Stunden Fahrt endlich in Linz ankamen, waren Aufregung und Müdigkeit schnell vergessen als sie sahen, wie toll die Linzer Schülerinnen und Schüler den Empfang vorbereitet hatten: geschmückte Willkommensplakate, Lichterketten, Taschenlampen und die meist mit der gesamten Familie wartenden Austauschpartner gaben dem stockdunklen Busparkplatz am Rhein direkt ein freundliches Gesicht.
Und diese gute Atmosphäre sollte sich durch die gesamte Austauschwoche ziehen. Eine Wanderung auf den Drachenfels bei strahlendem Sonnenschein mit allen Familien stimmte auf das Wochenende ein. Am Feiertag stand dann ein großer Kennenlerntag mit Spielen in deutsch-französischen Teams, Pizza, viel Kuchen und gemeinsamen Liedern zu Herrn Geldners Gitarre auf dem Plan, bei dem sich zeigte, dass sich die Gruppe übers Wochenende schon gut kennengelernt hatte. Ausflüge nach Köln und Bonn und der traditionelle Empfang beim Linzer Bürgermeister Dr. Faust rundeten das Programm ab. Die Zeit verging wie im Flug und alle freuen sich auf den Besuch in Pornic, auch wenn es bis Juni noch ganz schön lang ist!
A. Esser, 28.10.2022
![]() |
![]() |
![]() |
Europa zu Gast - Internationaler Besuch am Martinus-Gymnasium Linz
Franzosen und Polen lernen das MGL und Linz kennen
Endlich, nach 2 Jahren coronabedingter Zwangspause, konnten Schülerinnen und Schüler aus Pornic wieder nach Linz reisen! Der Traditionsaustausch ermöglicht jungen Franzosen und Deutschen seit mehr als 30 Jahren, das Nachbarland und seine Menschen kennenzulernen. Antje Eßer, Richard Geldner und Andrea Hermelingmeier (RKS) arbeiten eng mit ihren französischen Kollegen Kévin Jamet, Laure Pariyar und Organisatorin Gaëlle Martienne zusammen.
Europa zu Gast - Internationaler Besuch am Martinus-Gymnasium Linz

Franzosen und Polen lernen das MGL und Linz kennen
Endlich, nach 2 Jahren coronabedingter Zwangspause, konnten Schülerinnen und Schüler aus Pornic wieder nach Linz reisen! Der Traditionsaustausch ermöglicht jungen Franzosen und Deutschen seit mehr als 30 Jahren, das Nachbarland und seine Menschen kennenzulernen. Antje Eßer, Richard Geldner und Andrea Hermelingmeier (RKS) arbeiten eng mit ihren französischen Kollegen Kévin Jamet, Laure Pariyar und Organisatorin Gaëlle Martienne zusammen.
Durch die Auflösung von Nonnenwerth sind nicht nur viele neue Schülerinnen und Schüler und einige Lehrer zu uns ans MGL gekommen, wir konnten auch den seit 16 Jahren bestehenden Austausch mit Polen übernehmen, worüber wir sehr froh sind. Helmut Meixner, neuer Mittelstufenkoordinator, organisiert seit diesem Jahr den Austausch mit dem Don Bosco Lyzeum in Krakau. 13 Schülerinnen und Schüler, begleitet von ihren Lehrerinnen Urszula Król und Nina Kawczyk, haben sich auf den Weg in die Bunte Stadt am Rhein gemacht und lernen, wie die französischen Schülerinnen und Schüler Linz, Bonn, Köln und Koblenz kennen. Eine Wanderung zum Drachenfels und eine Stadtrallye durch Linz gehören natürlich auch immer zum Programm.
Wir hoffen, dass die jungen Menschen Botschafter eines friedlichen Europas werden!
Claudia Herzog, 06.10.2022
Courage-Scouts am MGL
Seit 2013 ist das MGL Mitglied im Netzwerk SOR-SMC - Schule ohne Rassismus, Schule mit Courage. Mit der jetzt erfolgreich abgeschlossenen 3-tägigen Ausbildung zum Courage-Scout haben sich engagierte Schülerinnen und Schüler der 9. bis 11. Jahrgangsstufe auf den Weg gemacht ein Konzept zu erarbeiten, um bei ihren Mitschülern und Mitschülerinnen das Bewusstsein für die Problematik von Alltagsrassismus zu schärfen
Courage-Scouts am MGL

Courage-Scouts am MGL Seit 2013 ist das MGL Mitglied im Netzwerk SOR-SMC - Schule ohne Rassismus, Schule mit Courage. Mit der jetzt erfolgreich abgeschlossenen 3-tägigen Ausbildung zum Courage-Scout haben sich engagierte Schülerinnen und Schüler der 9. bis 11. Jahrgangsstufe auf den Weg gemacht ein Konzept zu erarbeiten, um bei ihren Mitschülern und Mitschülerinnen das Bewusstsein für die Problematik von Alltagsrassismus zu schärfen.
Sie haben in Workshops Ideen entwickelt und werden in allen 5. und 6. Klassen eine Schulstunde präsentieren, um die Jüngeren auf die Thematik aufmerksam zu machen. Dabei soll für alle Diskriminierungsformen wie z.B. Antisemitismus, Sexismus, Body-Shaming, Queerfeindlichkeit um nur einige zu nennen, sensibilisiert werden. Unterstützt werden unsere neuen Courage-Scouts vom NDC, dem bundesweiten Netzwerk für Demokratie und Courage, das sich für Demokratieförderung und gegen menschenverachtendes Denken einsetzt.
Wer gerne bei einer der nächsten Schulungen mitmachen möchte, meldet sich bitte bei Frau Jäger oder mir.
C. Herzog, 27.09.2022
Endlich geht es los… - Herzlich willkommen am MGL!
Am Dienstag, den 06. September 2022, starteten 103 neue Fünftklässlerinnen und Fünftklässlern am Martinus-Gymnasium. Bei strahlendem Sonnenschein begrüßten Schüler des Religionskurses der Jahrgangsstufe 6 von Frau Herzog die neuen Schülerinnen und Schüler und ihre Eltern und Großeltern.
Endlich geht es los… - Herzlich willkommen am MGL!

Am Dienstag, den 06. September 2022, starteten 103 neue Fünftklässlerinnen und Fünftklässlern am Martinus-Gymnasium.
Bei strahlendem Sonnenschein begrüßten Schüler des Religionskurses der Jahrgangsstufe 6 von Frau Herzog die neuen Schülerinnen und Schüler und ihre Eltern und Großeltern.
Dazu gab es ein musikalisches Rahmenprogramm durch den Unterstufenchor unter Leitung von Herrn Lehmann. Nach den Grußworten von Schulleiter Thomas Schmacke und Frau Eva-Maria Dech, unserer Schulseelsorgerin und gleichzeitig Vertreterin der Kirchen in Linz, war es endlich soweit: Stolz zogen unsere Neuen, begleitet von ihren Klassenlehrerin oder ihrem Klassenlehrer und ihren Patinnen und Paten, in die Klassenräume und strahlten dabei mit ihrer Sonnenblume, die jedes Kind zur Begrüßung erhalten hatte, um die Wette. Die Eltern blieben auf dem Schulhof zurück und konnten, verwöhnt vom Schulelternbeirat mit Kaffee und Plätzchen, erste Kontakte untereinander knüpfen und die Eindrücke des feierlichen Beginns auf sich wirken lassen.
Wir wünschen allen neuen Mitgliedern unserer Schulgemeinschaft einen guten, erfolgreichen Start und weiterhin so viel Freude und Motivation wie am ersten Tag!
Sonja Kosch, 13.09.2022
(Orientierungsstufenleiterin)

„Breathe2Change“ – Die neue Feinstaubmessanlage am MGL
Ab diesem Sommer nimmt das MGL als Beitrag zur Verwirklichung der BNE-Ziele an dem Pilot-Projekt „Breathe2Change“ zur weltweiten Online-Dokumentation der Feinstaubbelastung teil. In Zusammenarbeit mit Herrn Dr. Kurtenbach von der Bergischen Universität Wuppertal wurde zu Beginn der Projekttage eine selbstgebaute Messstation installiert.
„Breathe2Change“ – Die neue Feinstaubmessanlage am MGL

Ab diesem Sommer nimmt das MGL als Beitrag zur Verwirklichung der BNE-Ziele an dem Pilot-Projekt „Breathe2Change“ zur weltweiten Online-Dokumentation der Feinstaubbelastung teil. In Zusammenarbeit mit Herrn Dr. Kurtenbach von der Bergischen Universität Wuppertal wurde zu Beginn der Projekttage eine selbstgebaute Messstation installiert. Diese besteht, wie Herr Kurtenbach den Schülerinnen und Schülern des Repair-Cafes und der AG Wertstoffverdichtung (Weißenfels/Söhl) erläuterte, aus einer Sensor-Einheit, welche sich in einem durch 3D-Druck erzeugten, wetterfesten Plastik-Gehäuse befindet und einer autarken CO2-neutralen Stromversorgung aus Solar-Panel und Akku. Die Montage der Komponenten hatte Herr Kurtenbach innerhalb von 20 Minuten erledigt und somit brauchte die komplette Anlage nur noch mit einem dafür eingerichteten Netzwerk des MGL verbunden zu werden. Regelmäßig werden nun in einem Zeitintervall von 10 Minuten sog. „vorskalierte“ Messdaten, insbesondere über die Feinstaubbelastung in der Einfahrt des MGL unter folgenden Internetadresse veröffentlicht: http://breathe2change.roblelab.com.ar/map
Wer allgemein mehr über das Projekt erfahren möchte, der möge sich unter der folgenden Internetadresse informieren: https://www.neuerweg-group.com/
![]() |
![]() |
Ansprechpartner:
![]() |
![]() |
| Herr Dr. Kurtenbach (Universtät Wuppertal) | Herr Dr. Söhl (MGL) |
Nachhaltigkeit am MGL – Projektwoche am Martinus-Gymnasium
In der letzten Woche vor den Sommerferien fanden am Martinus-Gymnasium Projekttage zum Thema Nachhaltigkeit statt.
Seit 2020 gibt es den Nachhaltigkeitsausschuss am MGL, die Schulgemeinschaft begleitet und gemeinsam mit ihr Ideen für eine lebenswerte Zukunft sammelt. Wir sind bereits Nachhaltige Schule und auf dem Weg zur BNE-Schule. Da ist es nur logisch, dass wir als Motto unserer Projektwoche die 17 Ziele der Nachhaltigkeit ausgewählt haben.
Nachhaltigkeit am MGL – Projektwoche am Martinus-Gymnasium

In der letzten Woche vor den Sommerferien fanden am Martinus-Gymnasium Projekttage zum Thema Nachhaltigkeit statt.
Seit 2020 gibt es den Nachhaltigkeitsausschuss am MGL, die Schulgemeinschaft begleitet und gemeinsam mit ihr Ideen für eine lebenswerte Zukunft sammelt. Wir sind bereits Nachhaltige Schule und auf dem Weg zur BNE-Schule. Da ist es nur logisch, dass wir als Motto unserer Projektwoche die 17 Ziele der Nachhaltigkeit ausgewählt haben. Das Programm bestand aus 26 Projekten, in denen 630 Schülerinnen und Schüler und 66 Lehrerinnen und Lehrer sich engagiert für die Ziele einsetzten. In vielfältigster Weise wurden Facetten der Möglichkeiten einen positiven Handabdruck zu hinterlassen beleuchtet.
[LINK zum Video der Projektwoche]
. Hier nur einige Projekte exemplarisch:
Wanderungen mit dem Revierförster, Upcycling von Elektrogeräten und Stoffresten, Fahrradfahren und Inspektion der Radinfrastruktur auf dem Stadtgebiet, Informationen zur aktiven Müllvermeidung und Recycling von Rohstoffen, interessante Chemie Experimente zu Wasserstoff oder die erfolgreiche Nutzung von Ressourcen. Es gab auch kreative Tätigkeiten, wie das Modellieren von Ton, wobei die Schülerinnen und Schüler verschiedenste Techniken kennenlernen und auch umsetzen konnten. Um Nachwuchs für den Schulsanitätsdienst (SSD) zu finden und zur Gesundheitsförderung beizutragen, gab es einen Erste-Hilfe-Kurs des DRK für interessierte Schülerinnen und Schüler der Klassenstufen 8-10. Außerdem hatten die Jüngeren die Möglichkeit, an einem Hate-Speech-Projekt oder an einem Toleranz- und Anti- Diskriminierungs-Projekt teilzunehmen, um über Hass und Hetze im Netz aufgeklärt und sensibilisiert zu werden. Zudem gab es Filme über Nachhaltigkeit, ein vom Land RLP gefördertes Ernährungsprojekt, in dem es um die Zubereitung regionaler Produkte ging, eine Fortbildung über heimische Kräuter und die Möglichkeit diese in neuen Rezepten zu verarbeiten. Großen Anklang fanden auch die Projekte, die reelle statt virtuelle Spiele auf dem Plan hatten, die Ausflüge zum Hof Roning und Hühnerhof Heinrichs in Bruchhausen. Frei nach dem Motto: Ein gesunder Geist wohnt in einem gesunden Körper gab es auch Projekte zu körperlicher und psychischer Gesundheit sowie nachhaltigem Sport. Abgerundet wurden die Projekttage noch durch handwerkliches und künstlerisches Engagement in der Musical- und Verschönerungstruppe und einen Clean-Up des Stadtgebietes.
Alles in allem tolle Tage, die jedem Perspektiven und Möglichkeiten aufzeigte, fit für die Zukunft zu werden.
C. Herzog, 22.07.2022
![]() |
![]() |
![]() |
![]() |
![]() |
![]() |
![]() |
![]() |
![]() |
![]() |
![]() |
![]() |
![]() |
![]() |
![]() |




































































































































